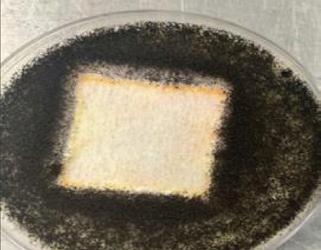

ANNUAL 2025 FILTRATION INNOVATION ISSUE





GOVERNANCE
A Strategic Framework for Filtration, Trade, and Sustainable Governance
REVERSE OSMOSIS Environmental Challenges SHOW PREVIEWS World Filtration Institute AHR 2026 TM








Corporate Profile A2Z Filtration Specialities
Solution Center Epic Resins
Innovation in Action: Filtration for Today ... and Tomorrow
Compiled By Caryn Smith, Chief Content Officer & Publisher, IFN
Synergizing Clean Energy & Clean Air
38 / Excerpts from the Experts By Dr. Iyad Al-Attar, Global Correspondent, Technology and Innovation, IFN
Reverse Osmosis: Innovations for Environmental Challenges By Jason Chen, International Correspondent, IFN
Progressive Filtration for Cleaning Metalworking Coolants
By James J. Joseph
Show Previews
47 / World Filtration Institute
48 / AHR 2026
COLUMNS & DEPARTMENTS
Viewpoint
Innovation Grows – And a Personal Note By Caryn Smith, Chief Content Officer & Publisher, IFN
Tech Spotlight
Keeping the Real World Out of Diesel Equipment
Tech Notes
New Technology Briefs Green Economy
Embracing Circularity in Filtration By Philippe Wijns, Principal, CleverSustainability Emergence
Trending University & Institutional Research
Compiled By Ken Norberg, Editorial & Production Manager, IFN Movers & Shakers
Industry News & Notes

















Caryn Smith Chief Content Officer & Publisher, INDA Media csmith@inda.org

Dr. Iyad Al-Attar Global Correspondent, Technology & Innovation, Visiting Academic Fellow Cranfield University i@driyadalattar.com

Philippe Wijns Principal, CleverSustainability, Filtration Expert and Sustainable Business Development Advisor philippe.wijns@ cleversustainability.com
CALL FOR COLUMNISTS & WRITERS

Jason Chen International Correspondent jasonchen200501 @hotmail.com

James J. Joseph Author and Consultant Joseph Marketing +1 757.565.1549 josephmarketing120@ gmail.com
International Filtration News is actively seeking viewpoints from qualified industry professionals and those allied to the filtration industry for insightful columns on topics such as trends, innovation, equipment, processes, etc. Email Caryn Smith, csmith@inda.org with feature and column ideas.






Innovation Grows – and A Personal Note
“Creativity is thinking up new things. Innovation is doing new things.” — Theodore Levitt
Creativity is something I feel I excel at, and I must say that I am not shy about sharing my ideas with others, almost to a fault. I mean, why wouldn’t you want new ideas to shape the future of your widget? But I have found that, sometimes, people just want a slightly better version of status quo, not reinvention of the wheel. To each their own!
Yet, I am happy to report that what you will find in this issue of IFN are the folks that embrace ideas, and then DO SOMETHING about them. My kind of people. The Innovators.
On page 22, the Annual Innovation Roundup contains those in the filtration industry pushing the envelope in small and big ways. Four years ago, I started this annual tradition to highlight “the best of” in the last issue of the year. I found it interesting that submissions only trickled in, at best. This year, I think the idea has come into fullness, as we had many entries, and I love the vibe of this issue! I hope it inspires you.
Other big ideas in this issue include Embracing Circularity on page 14, IAQ Governance on page 34, Reverse Osmosis and the Environment on page 42. You have a chance to be inspired at two upcoming shows, as well – WFI ‘25, page 47, and AHR ‘26, page 48.
Speaking of new ideas, the Media Kit 2026 was just released and is found at https:// www.filtnews.com/advertise/. This year our theme is “New Dimensions Through Partnership & Collaboration.”

I strongly feel that from the editorial to the advertising of this publication, it is a true industry collaboration to benefit you, the reader. Ultimately, you want to learn about news and views that help you to stay ahead of the curve and, hopefully, be inspired to formulate your own innovative ideas!
In the Media Kit, we share an Editorial Grid, full of new and interesting issue topics for next year, such as a focus on Data Centers, Digitization and AI, Gas Turbine Filtration, Industrial Water Trends, Equipment and Machinery, Production Efficiency and more.
To discuss your ideas for an article in one of our issues, or to collaborate on marketing or advertising, email csmith@inda.org.
Let’s Talk Partnership & Collaboration!
Caryn Smith Chief

Content Officer
& Publisher, INDA Media, IFN
International Filtration News Editorial Advisory Board
R. Vijayakumar, Ph.D., Chair AERFIL
Tel: +1 315-506-6883
Email: vijay@aerfil.com
Jay Armstrong, MBA, PhD Mott Corp.
MS Teams #: +1 (860) 999-9035
Email: JArmstrong@mottcorp.com
James J. Joseph
Joseph Marketing
Tel/Fax: +1 757-565-1549
Email: josephmarketing120@gmail.com
Tom Justice, CAFS, NCT ZENE, LLC Filtration
Tel: +1 757-378-3857
Email: justfilter@yahoo.com
Wenping Li, Ph.D.
Agriltech Research Company
Tel: +1 337-421-6345
Email: wenpingl@agrilectric.com
Rishit R. Merchant Parker Hannifin
Tel: +1 805-604-3519
Email:rishit.merchant@parker.com
Thad Ptak, Ph.D.
TJ Ptak & Associates
Tel: +1 414-514-8937
Email: thadptak@hotmail.com
Philippe Wijns CleverSustainability
Email: philippe.wijns@cleversustainability.com
New Dimensions Through Partnership & Collaboration
MEDIA KIT 2026
SPOTLIGHT TECH
Keeping the Real World Out of Diesel Equipment
Industry-Standard Filtration Tests Aren’t Telling the Whole Story
By Greg Hoverson, Vice President and Chief Technical Officer, Atmus Filtration Technologies
Are industry standard tests keeping pace with evolving customer needs?
Standards play critical roles in keeping diesel equipment running, and they are needed. But when it comes to diesel fuel filtration, customer needs are evolving faster than standards can address.
Although standardized tests can provide insight into filter life and efficiency, they don’t always tell the whole story. Customers care about real-world performance and the bottom line. How well will their equipment be protected? How often will they need to service the filter? How will their filtration needs impact their total operating costs?
To enable our customers’ success, we must also go beyond industry testing to provide filtration solutions that more closely simulate the dynamic and real-world conditions our customers experience.
Old Standards Aren’t Keeping Pace With New Challenges
Technological developments and changing market needs are creating challenges that current standardized test methods aren’t equipped to handle.
For example, a trucking fleet in Brazil recently experienced widespread short service life or cycle issues. Everything from macroeconomic shifts in the biodiesel supply base to advances in fuel systems – two factors not easily identified through standardized testing – caused their filters to fill up with contaminants twice as fast, resulting in short service life while causing unplanned and unwanted maintenance.
Standardized methods run capacity tests with hard dust particles of a certain size for a set period. But this isn’t always representative of what plugs a filter in today’s operating
conditions. Today, filters are more likely to be plugged with soft, sticky organic material with smaller particles, especially if biofuels are blended in.
In Brazil, the customer needed to get to the root of the problem right away but knew it required more than standardized data. They turned to Atmus Filtration Technologies for help.
Atmus was able to deploy on-site fuel testing to analyze and understand the real-world fuel contamination. Then, recreating these conditions in the lab resulted in a more effective solution that captured smaller particles –protecting the engine, extending service life and delivering the expected service intervals.
Greater Fuel Variation Is the New Normal
A decade or two ago, it was possible to take a “one-size-fits-all” approach to filtration technology, in part because engine and fuel system designs provided more clearance. The same systems would deliver comparable performance, whether they were used in North America, South America, Europe or anywhere else. This approach doesn’t work anymore. The biggest factors our customers face include:
• Changes in diesel fuel-injection equipment – Most modern diesel engines use a high-pressure common rail (HPCR) fuel system or similar technology to meet stricter emissions standards. This type of equipment is extremely sensitive to small particles; it’s now necessary to protect the system from smaller particles than in the past (typically four microns, or smaller than a red blood cell). Filters today must capture more material, meaning they are at risk of plugging faster. Innovation is therefore necessary to extend service intervals.

• Modern pressurized fuel systems – Pressurizing fuel raises its temperature, creating more contamination as it moves through the system. As a result, filters are up against additional contaminants that weren’t generated by the mechanical or electrical fuel systems of the past.
• Aging infrastructure – Many of the world’s fuel pipelines are aging. Fuel delivered through aging pipes dislodges rust and other contaminants that have built up over time, carrying them into the distribution system. Each fill-up delivers fuel pumped through different pipelines, giving customers less control over what their systems are exposed to. Filters need to be ready for anything.
• Biofuel content – There’s significant variability in global biofuels, even in the U.S., where biodiesel blends up to B5 don’t have to be labeled. Although these fuels can often be used as drop-in replacements for ultra-low sulfur diesel, their chemistry can present different challenges to filter life and performance.
All these factors are driving the need for greater innovation to create more capacity in filters so that customers don’t have to settle for shorter service intervals. Going beyond industry standard testing can help us get there.
Protecting Your Equipment
Next time you are evaluating a filtration solution, ask yourself how it will perform for your application. Look for a provider who can demonstrate that they’ve gone beyond industry standard tests to test for real-world performance. www.atmus.com
For details on how to submit your company’s technology for consideration as a “Technology Spotlight” in IFN , contact Ken Norberg at ken@filtnews.com or +1 202.681.2022.
NOTES TECH
Crown Unveils
Patent-Pending Monarc Clean Oilseed ProcessingTM

Crown announces Monarc Clean Oilseed ProcessingTM, a revolutionary, patent-pending alcohol-based solvent extraction technology that is projected to have competitive operational efficiency to traditional hexane-based extraction systems while delivering key advantages in safety, environmental impact and consumer appeal. This makes it possible for alcohol-based solvent extraction to compete with hexane-based extraction at scale. Historically, oilseed processors have relied on hexane-based extraction as the most efficient and cost-effective method to produce the cooking oils, protein meals and ingredients that form the foundation of countless food products consumed worldwide.
Now, Monarc Clean Oilseed Processing allows producers to work with alcohol-based solvents, like ethanol, and take advantage of meaningful benefits:
• Alcohol is already present in or utilized to produce many foods and beverages.
• The use of an alcohol-based solvent enables companies to produce clean-label products that appeal to health-conscious consumers.
• Alcohol-based solvents significantly improve worker safety profiles at factories.
• Alcohol-based solvents reduce environmental impact compared to petroleum derivatives like hexane.
• Alcohol-based solvents better align with sustainability goals.
• Alcohol is a renewable source material, as ethanol can be produced from plants.
• Alcohol-based solvents facilitate easier permitting of new extraction facilities compared to hexane. https://onecpm.com
Pall Enables Sustainable Food Production at a Lower Cost with Membralox®

Pall Corporation, a leading provider of filtration, separation and purification solutions launched Membralox ® GP-IC ceramic membrane systems, a revolutionary ceramic membrane with graduated permeability along the length of the filter. This unique design increases processing efficiency, lowers capital and operating costs and has the potential to yield up to 95% recovered value-add products enhancing overall filtration performance.
With a high surface area and multi-channel geometry, the Membralox GP-IC membranes offer up to 45% more filtration capacity compared to conventional ceramic filters of similar size. This enables optimized system loop design with more compact filter modules, reducing capital and operational expense.
“The unique design of Membralox GP-IC pushes the boundaries of what’s possible for ceramic membrane solutions in order to meet the demands of food processors globally,” said Ankush Soni, Vice President & General Manager of the Food and Beverage business unit of Pall Corporation. “We are excited to launch this breakthrough solution and support our customers with a smarter, more efficient and sustainable solution.”
Pall has a long history of expertise and innovation in the ceramic membrane industry, which is poised for exponential growth ($21 billion by 2030). Through filtration expertise as well as a deep understanding of the unique challenges of the global food industry, Pall was able to design a solution enabling customers to be at the forefront of sustainable and efficient food production. www.pall.com

Transfilm Technology, a global leader in reverse osmosis and nanofiltration membrane research, development, and manufacturing, recently announced the launch of IonClear, a Silicon Valley-based company that supplies water filtration and resource recovery membranes for customers across North America and beyond. IonClear will serve American, Canadian and Mexican markets.
Transfilm Technology was established by a team of international scientists specializing in membrane research, development, and production for water filtration, reclamation, and reuse. The company operates a global network providing water purification solutions for markets around the world.
Cady Yu, CEO of Transfilm and IonClear, said: “The launch of IonClear in the United States marks an exciting new chapter for Transfilm. By combining our decades of scientific expertise with U.S.-based operations, we will be able to accelerate innovation, strengthen supply resilience, and deliver sustainable, high-performance water treatment solutions with closer-to-market innovations.” www.transfilmtech.com
Transfilm Debuts IonClear
TRANSFILM Reverse Osmosis Elements.
Pall Membralox GP-IC ceramic membranes
Monarc Clean Oilseed ProcessingTM, a revolutionary, patentpending alcohol-based solvent extraction technology. Crown
Blu Technology Launches ‘Camo’ Water Filtration System
Blu Technology, a leader in mobile water filtration solutions, has launched a limited-edition camo version of its AR3 3-Stage Water Filtration System.
The product was unveiled at America’s Largest RV Show in Hershey, Pa., and is designed to provide cleaner, safer water when traveling by RV and a custom option for the outdoor enthusiasts’ gear checklist, according to a release.
Blu Technology has already seen success with its original, bright blue version of the AR3 system (nicknamed “The Blu” by RV influencers and Blu Technology customers). The new product, with its camouflage detailing, seeks to pique the interest of campers, hunters and anglers as well. “Beneath its rugged exterior lies the same advanced RV water filtration technology trusted by thousands of RVers nationwide,” said Corbin Collet, Blu Technology’s CEO and founder.
“The AR3 is engineered and assembled in Kalamazoo, Michigan and features a smaller micron size, stage two filter for greater filtration,” Collet added. Standard RV inline water filters are able to filter out particles up to 20 microns in size. Blu Technology 0.2-micron filters provide filtration for particles that are up to 100x smaller.
The three-stage process includes:
• Longevity Filter: Captures larger particles, including dirt, sand, and rust.
• 0.2 Micron Filter: Reduces sub-micron contaminants including bacteria and viruses.
• Tasty Filter: Improves the taste and smell of water via its granularactivated filter.

Blu Technology’s AR3 camo version.
The limited-edition design is created for RVers who see the road as more than just a route to follow but rather a lifestyle to define instead. The Limited Edition AR3 3-Stage Water Filtration System Camo Version celebrates that adventurous spirit and has “collector’s piece” status for those who love the outdoors, off-grid camping, and fall travel. www.goblutech.com
Toray Launches Industry-Leading Reverse Osmosis Membrane
Toray Industries, Inc., announced the launch of the TLF-400ULD reverse osmosis (RO) membrane that was developed with Toray Membrane (Foshan) Co., Ltd., and Toray Advanced Materials Research Laboratories (China) Co., Ltd., for industrial wastewater reuse and sewage treatment.
The TLF-400ULD offers several advantages over conventional counterparts. It uses Toray’s proprietary membrane manufacturing technology and flow-channel design to improve permeability and chemical resistance while maintaining high salt rejection. It slashes differential pressure increases from fouling.
Toray’s innovative design doubles chemical resistance during cleaning while boosting permeability. This suppresses performance
ZwitterCo Launches Evolution Membranes, Transforming Dairy and Food Processing Efficiency

ZwitterCo, a global leader in membrane solutions for challenging liquid separations, has announced the commercial release of its Evolution membrane product family. These next-generation membranes are engineered to help food, dairy, and biotech processors increase productivity, reduce cleaning costs, and advance sustainability objectives – all without requiring changes to existing systems.
In dairy and food processing, every minute counts, but lengthy daily cleanings can consume valuable production time and significantly increase chemical consumption and water demand. Evolution membranes, built with ZwitterCo’s patented zwitterionic chemistry, are anti-fouling and fully recover performance with a simplified cleaning program. This enables processors to clean faster, use fewer chemicals, and reclaim over an hour per day for additional production or other high-value tasks.
Available in an ultrafiltration membrane for protein concentration (PCM), superfiltration (SF), and reverse osmosis (RO) membrane configurations, Evolution membranes are one-for-one replacements for conventional sanitary spiral membranes. They install easily in existing systems with no hardware changes needed to experience lower operational costs and time savings. zwitterco.com
deterioration and extends service life.

A clog-resistant element structure reduces fouling buildup and cuts chemical cleaning frequency. Together, these features enable stable long-term operation while consuming roughly 10% less energy. The TLF-400ULD should reduce membrane replacement frequency and simplify operational management.
Global water shortages are driving demand for water treatment technologies that handle diverse water sources, operate efficiently, and reduce environmental impact. As a nextgeneration solution, the TLF-400ULD will help build energy- and resource-efficient processes at water treatment sites worldwide.
China’s 14th Five-Year Plan for Circular
Economy Development (2021–2025) has accelerated the adoption of water treatment membranes to combat water pollution. Toray has established an integrated structure in China covering research, development, production, and sales through Toray BlueStar Membrane, Toray Membrane (Foshan), and Toray Advanced Materials Research Laboratories (China). These companies will collaborate to deliver optimal local solutions while working with Toray’s global water treatment group. Together, they will contribute to solving the world’s water challenges by providing advanced membrane technologies, including the TLF-400ULD, along with responsive technical services. www.toray.com
ZwitterCo’s Evolution membranes.
NOTES TECH
Nobel Prize for MOFs Developers
Svante Technologies Inc., headquartered in Canada is celebrating the recent announcement of the 2025 Nobel Prize in Chemistry, which honored scientists Susumu Kitagawa, Richard Robson and Omar Yaghi for their groundbreaking work in the field of metal-organic frameworks (MOFs).
The Royal Swedish Academy of Sciences awarded the prize for the development of MOFs, citing their “enormous potential” and unique molecular architecture that creates spacious, porous materials capable of capturing and storing specific substances, including carbon dioxide.
“The Nobel Committee’s recognition of the very class of materials we leverage here at Svante is a profound validation for the entire field of carbon capture and removal,” said Svante COO and President Richard Laliberté. “The cutting-edge work that is being done in the MOF space has been one of the fundamental building blocks of our success in this industry.”

t Svante’s CALF-20 MOFs. Svante
The Nobel announcement highlighted the incredible capability of MOFs for gas separation and high-capacity capture, which are central to Svante’s proprietary filter technology. Specifically, the scientific background documents referenced MOFs relevant to industrial carbon capture, including CALF-20, a MOF developed by Dr. George Shimizu at the University of Calgary, a valued collaborator, scientific advisor and inventor of the MOF used by Svante.
Svante manufactures structured adsorbent filters coated in solid sorbent materials at industrial scale, including CALF-20, a MOF that the company has successfully scaled up from gram to commercial quantities in collaboration with its partners in the materials sciences sector. Svante recently launched Svante OEM&D, a new business unit that helps customers with solid sorbents get gas separation technologies to market faster, leveraging Svante’s expertise, experience and equipment to scale up solid sorbents and coat them onto high-performance filters. www.svanteinc.com



MINI-PLEAT-GLASS
Mini-Pleat: H.E.P.A., ULPA & ASHRAE
Pleat heights 1/2” to 12” upto 39” wide. Interrupted beads, many configurations.
Mini-Pleat: H.E.P.A. & ASHRAE
Pleat heights 3/4” to 4” upto 25” wide. Interrupted beads, many configurations.

Share Your Knowledge, Research, and Best Practices
This year's theme, Energy Transition & Regulatory Compliance, spotlights the pivotal role of filtration and separations in enabling cleaner energy systems and meeting increasingly complex global standards.
From renewable fuels and hydrogen production to carbon capture, battery technologies, and advanced manufacturing, innovations in filtration are driving efficiency, reliability, and sustainability across sectors.
And as emerging technologies and AI-driven design reshape the landscape, FILTCON26 offers a platform for scientists, engineers, and practitioners to share breakthroughs, discuss evolving regulations, and explore solutions that will define the next generation of clean technology.
Submit your abstract today and contribute to advancing the science and practice of filtration in a changing world.

www.afssociety.org/filtcon26/call-for-abstracts
Submission Deadline: Dec. 15
A2Z Truly Has The “Widest Range for End Caps & Components”
A2Z Filtration Specialities manufactures a large variety of end caps, components, and parts to suit the assembly of all types of filters. A2Z supplies products in sheet metal duly Stamped, Machined, Cast as well as Injection Molded parts. With a range of over 7,000-part numbers, we offer the broadest range of end caps on earth. Only the latest version of SolidWorks® is used to design all tooling. The ability to manufacture our own tooling with HAAS® CNC machines allow us to quickly turn around parts from concept to finished product in less than three weeks.
A2Z Supplies:
• End Caps – Stamped and supplied in Zinc, Tin, Nickel, Powder Coated. Also available in spun and fabricated.
• Expanded metal is available as cut-tosize sheets as per the specification of the customers or in coils in Galvanized steel, Stainless steel, Aluminum, and powder coated.
• Injection molded parts can be supplied in Glass-filled nylon (any grade), ABS, Polypropylene, Silicon, Polyester and Polycarbonate materials. The above components can be supplied in various grades materials including FDAapproved.
• CNC Machined Parts in materials such as Steel, Stainless Steel, Aluminum, Brass and Nylon.
• Synthetic Rubber Grommets, Gaskets, Sponge Rubber Air Filter Molded Sealing Rings (endless/jointless). Available in EPDM, Natural Rubber, Silicone among other materials as per requirement.
• Weld Mesh Cages of any size or configuration.
• Deep drawn housings and Threaded Top cover plates for spin-on filters.
• Perforated Sheets (Tin, Mild Steel, Zinc Plated or Paper Board)
• Panel Sets and Frames
The illustration showcases over 50,000 square feet of area used for storage of over 7,000 tools and dies.
A2Z Has the Infrastructure to Meet All Your Needs
1. With a total covered area of nearly 200,000 square feet.
2. Over 11 Solid workstations for Design.
3. A tool room is spread over 50 thousand square feet and consists of 11 Haas ® CNC Machines over 13 mechanical lathes, surface grinders, milling machines. At any given time A2Z carries over 500 tons of various grades and


thicknesses of stainless steel and steel materials.
4. We have spot welding, projection welding, MIG welding, TIG welding, capacitor discharge projection welding and stud welding machines.


5. Over 80 pneumatic power presses, hydraulic presses, double action presses with the range from 10 tons to 250 tons spread over 100,000 square feet. We can offer a quick turnaround of your orders.
6. We also have multiple turret punch press and CNC hydraulic press brake machines to manufacture a large range of frames and punched parts.
7. Five Dedicated High Speed Automated Expanded Metal Lines to produce expanded metal in various raw materials.
8. State of the Art Inspection System, such as Carl Zeiss – CMM – Mitutoyo Contracer and various measuring instruments from Mitutoyo.
9. In-house Sand Blasting facilities. A2Z is the go-to supplier for all your component needs. A2Z also has the ability to provide supplies through 3rd party warehouses in North America.

For further information, please visit our website –www.a2zfiltration.com or contact us at info@a2zfiltration.com
TURRET PUNCH PRESS MACHINE.
CNC HYDRAULIC PRESS BRAKE MACHINE.

Improving Efficiency, Product Life and Production Without Compromising Performance
In high-performance filtration systems, choosing the right adhesive plays a crucial role in the integrity, durability and efficiency of the final product. As engineers and manufacturers face increasing demands for heat resistance, chemical resistance and production efficiency, selecting the right adhesive is more important than ever. Epic Resins, a global leader in epoxy and polyurethane technology, develops solutions tailored to meet these evolving challenges.
Epic Resins has formulated, manufactured and supplied high-quality epoxy resins and polyurethanes to a wide range of industries for over 65 years. Specializing in adhesives, potting and encapsulation compounds, Epic Resins delivers products to enhance customer profitability and performance.
Because Your Design Can NOT Be Compromised
The launch of Epic S7465 highlights Epic Resins’ commitment to helping customers:
• Improve manufacturing efficiency
• Extend product life in demanding environments
• Streamline production without compromising performance

Whether you’re a spa equipment supplier wanting a filter end cap material, an OEM supplier seeking an air filter potting compound or an automotive manufacturer looking for a chemical resistant filter adhesive, Epic Resins can formulate it.
S7465: A 3-in-1 Epoxy System
Epic’s S7465 is a two-component epoxy adhesive specifically designed for high-temperature applications that require good chemical resistance. With its unique rheological design, S7465 stands out in the marketplace as a truly multi-functional material.
Key Benefits:
• 3-in-1 functionality: Can be used for seam sealing, moldable end-caps and end-cap adhesive
• Reduced work-in-process (WIP): Pot both end caps and apply the seam seal in a single step
• Streamlined operations: Short setup time
High-Temperature & Harsh Environment Performance
S7465 delivers reliable performance in extreme conditions:
• Temperature resistance: Up to 177°C
• Chemical resistance:
Excellent when immersed in harsh fluids, including:
- Automatic transmission fluid
- Synthetic hydraulic oil
- Synthetic water-free fluids (HFD-U)
- Water glycol fluids (WGF)

Above: S7465 is a multi-functional adhesive, it can be used in seam sealing, moldable end-caps and as an end-cap adhesive. Left: The chemists at Epic Resins work directly with your engineering and manufacturing departments, enabling us to provide you with effective solutions to fit your demanding needs.
Exceptional Bonding & Versatility
S7465 provides strong adhesion across a wide range of substrates:
• Excellent adhesion to end cap substrates
• Customizable viscosity: Available in multiple flowability options to suit various applications and dispensing methods
Production-Friendly Formulation
Designed with manufacturing efficiency in mind:
• Simple 4:1 volumetric mix ratio
• Short setup time: Speeds up filter production
• Reduced material changeovers: Supports lean manuacturing goals
Epic Resins: A Partner in Filtration Innovation
Epic Resins has a long-standing reputation for:
• Customized formulation support: Work directly with application chemists
• Responsive technical service: On-site troubleshooting and process guidance
• Consistent quality: Trusted materials that meet exact specifications
To learn more about Epic S7465 or to request a sample, visit www.epicresins.com.

By Philippe Wijns Principal at CleverSustainability, Filtration Expert and Sustainable Business Development Advisor
Embracing Circularity in Filtration
A Practical Framework and the New EU Circular Economy Act (2026)
Why is circularity suddenly featured in so many sustainability strategies, webinars, and conference discussions? Is it simply a buzzword, or does it have genuine regulatory and commercial backing? In Europe, much of this drive comes from new legislation commonly referred to as the EU Circular Economy Act, a blanket term for multiple enforceable laws that emphasize product design, encourage reuse and recycling, and demand transparent reporting throughout production and consumption. Start-ups are experimenting not only with repair services, refurbishment, and take-back schemes but also with innovative recycling and collecting initiatives. At the same time, chemical and polymer companies are shifting their focus from purely virgin raw materials to more sustainable and circular alternatives. Large filtration companies are adapting too – offering full-service models such as “Filtration as a Service” (BaaS), integrating recycling, product recovery, and lifecycle optimization. Across the industry, CO₂ footprint documentation and tracking of Scope 1, 2, and increasingly Scope 3 are becoming standard, or even mandatory, as part of CSRD, ESG, and financial disclosures. The filtration sector might be wellpositioned for these changes. The challenge now is to make circularity more than just a concept by applying it in measurable ways that enhance performance, reduce risks, and comply with regulatory frameworks – while also embedding it into the core of corporate sustainability strategies.
The EU “Circular Economy Act” –What It Is and What It Will Be
The European Commission launched a public consultation on August 1, 2025, for a new Circular Economy Act (CEA). The initiative aims to accelerate the EU’s transition to a circular economy with a central objective: Creating a single market for
Philippe Wijns is Principal at CleverSustainability, and serves as a Filtration Expert and Sustainable Business Development Advisor. He is a Certified Expert in Sustainable Finance, Climate Finance, and Renewable Energy from the Frankfurt School of Finance and Management. He began with global leaders in the nonwovens industry before transitioning to the filtration sector, where he specialized in filtration technologies across a wide range of applications and markets – including industrial and automotive systems, HVAC, household appliances, medical and life sciences, as well as power storage solutions such as fuel cells, hydrogen systems, and battery separators.
Wijns recently founded CleverSustainability, a consultancy dedicated to sustainable business development to help companies develop and implement sustainability strategies, ensure compliance with the EU legal reporting requirements, and enhance their sustainable business growth, product portfolio and development, and market positioning.
secondary raw materials, increasing the availability of high-quality recycled inputs, and stimulating demand across industries. According to the Commission’s timeline, a legislative proposal is expected in 2026. The Act is positioned within the broader Clean Industrial Deal and the EU Competitiveness Compass.
Relationship with existing legislation. The CEA will not replace existing rules such as the ESPR or the PPWR. Instead, it is intended to complement and build on measures already adopted under the 2020 Circular Economy Action Plan – including the ESPR (ecodesign and Digital Product Passports), PPWR (packaging), the Right-to-Repair initiative, waste shipment regulations, and more. The explicit goal is to ensure that markets for secondary raw materials can scale across borders, with the CEA acting as the connecting framework. This includes:
• Create a real single market for recycled materials.
• Pull demand and improve product design via existing levers.
• Target key product/value chains and close waste policy gaps.
• Tie circularity to EU competitiveness. The Commission opened the consultation window from August 1 to November 6, 2025, as part of the “Have Your Say” process, which feeds into its impact assessment. A legislative proposal for the Circular Economy Act is expected in 2026, after which it will move to Parliament and Council negotiations. Until the draft text is published, the exact targets, obligations, and standards remain open.
Practical implications of the EU Circular Economy Act (What This Likely Means for Operators and OEMs)
• Materials strategy: expect more straightforward rules and quality signals for recycled polymers/metals across borders.
• Product information & design: stricter use of Digital Product Passports under ESPR, including CO2 footprint information and tracking
• End-of-life systems: updates to waste/product-stream laws.
• Competitiveness & procurement: stronger demand-pull from public procurement and
private buyers for circular designs and verified recycled content as part of competitiveness policy.
An Operational Circularity Framework for Filtration
Across industries, circularity programs often organize work around four pillars spanning the full life cycle: Prevention (1), Preparing for reuse (2), Collection & Recycling (3), and Disposal (4).
• Prevention: reducing waste and emissions. Filtration products can reduce waste and emissions by utilizing single materials, safe chemicals, and designs that facilitate disassembly. Reusable frames, recyclable packaging, and intelligent monitoring extend product life while ensuring efficiency in HVAC, air, and water filtration systems.
• Preparing for Reuse: extending filter lifecycles. Extending filtration product lifecycles through reusable housings and frames that facilitate simple media replacement and cleaning enables reuse, adaptability, and a longer service life.

• Collection & Recycling: closing the loop. To promote circularity in filtration, companies should implement incentive-based take-back systems, design for easy product separation, and reuse plastics, metals, and fibers. When recycling isn’t feasible, safe energy recovery minimizes landfill use, while incorporating recycled materials into new products sustains demand and closes the loop.






From Today’s Practices to Collective Action
Today, many filtration companies are advancing circularity by focusing on prevention, preparation for reuse, collection and recycling, and responsible disposal. They are integrating design for longevity, modularity, and recyclability into products, embedding circular practices into daily operations, and aligning these with regulatory compliance. These steps strengthen operational efficiency, reduce environmental impact, and build long-term resilience. However, to accelerate progress and achieve scalability, the industry must not operate in isolation. Companies should standardize data and definitions for media, additives, and material IDs, enabling digital product passports and seamless service histories. They should also work toward unified systems for product returns, with consistent labelling, documentation, and return hubs co-funded by OEMs, media producers, and service networks. Joint research on material separation, safe decontamination, and refurbishment can make recycling and reuse more reliable in sensitive applications.



• Disposal: responsible end-of-life management. Some waste, such as biohazard filters or highly contaminated media, is unavoidable. Use strict handling, specialised treatments like energy-recovering incineration, and design feedback to continually reduce leftover waste.
Implementing a Circularity Score Model: Simple, Credible, Useful
Learning from other industries, we see that a circularity score model can be applied in any sector to turn complex sustainability data into clear, actionable insights. At its core, such a model is a measurement system that consolidates many data points – like return rates, recycled content, reuse volumes, and landfill avoidance – into a single score with drill-down KPIs. Instead of tracking dozens of isolated indicators, companies can group key performance indicators into a few KPIs aligned with their ESG strategy. Tracking these consistently over time makes it possible to demonstrate progress, identify gaps, and build trust with stakeholders. A consolidated score provides management focus, cross-functional alignment, and comparability across business units and markets – while giving customers, investors, and regulators a credible and transparent view of circularity performance.







This is where industry organizations have a crucial role: coordinating shared data standards, facilitating training programs, and creating frameworks for cross-border refurbishment, recycling, or energy recovery pathways. By adopting standard metrics such as a circularity score, the sector can track progress, benchmark reasonably, and ensure comparability. Drawing inspiration from other industries – such as electronics or apparel – filtration can tailor proven solutions in returns management, grading, and secondary use to its specific needs, including sterility, efficiency, and regulatory validation. The message is clear: Companies are already taking necessary steps, but industry-wide coordination will be the real accelerator for circularity in filtration.
Conclusion – Making Circularity Everyday Business
Circularity is transitioning from a side project to an integral part of our everyday practice, woven into our strategies, budgets, and customer promises. The road ahead is complex, challenging, and at times uncertain. Still, we don’t need to make it more complicated than it is: A clear, simple measuring system – a practical scorecard with a handful of indicators – helps everyone see where we stand, where we’re improving, and where we need to adjust. If companies, partners, and industry organizations align around this shared view, we can steadily expand return systems, trusted refurbishment and recycling routes, and reliable supply chains across regions and markets. Different sectors and geographies will start from various points, yet the direction is the same: Keep learning from one another, focus on what works, and show progress year over year. By staying pragmatic and collaborative, our industry won’t just keep pace with circularity – it will help set the pace for our customers.
EMERGENCE
Compiled by Ken Norberg, IFN Editorial & Production Manager
International Filtration News Explores Trending Innovation
IFN highlights significant research from universities and institutions around the world. If you are a part of a project you would like to highlight, email csmith@inda.org. Please write “IFN Emerging Research Submission” in your subject line in order to apply. Please send a completed press release and/or summary of the research as you would want it to be printed, a link to the university online story (if applicable), and all high resolution photographs/charts/graphs, short researcher bio(s). All selections could be edited for length.
IN THE NEWS
German Students Awarded 2025
Stockholm Junior Water Prize for Flood Warning Innovation
Niklas Ruf and Jana Spiller from Germany received the prestigious Stockholm Junior Water Prize 2025 for their work on developing a scalable flood warning system for small streams. H.R.H. Crown Princess Victoria of Sweden presented the winners with their award during a ceremony at Stockholm City Hall as part of World Water Week in Stockholm.
Flooding is an increasing concern worldwide, with more frequent and larger floods affecting communities. Yet on smaller streams, real-time data is often lacking, limiting the possibility of early warnings. Over four years of work, Ruf and Spiller created a network of sensors linked to an app that provides live alerts to both experts and the public. Their system is already being scaled up across their region in consultation with multiple partners.
The jury noted that the project “addresses a critical challenge we are seeing around the globe: more frequent and bigger floods. Yet on smaller streams, we often lack the data needed to provide real-time warnings. The students have not only built a functioning system and an app that notifies experts and the public, but they are also already working to scale this system across their region in consultation with numerous partners.”
Diploma of Excellence – Türkiye
The Diploma of Excellence was awarded to Kagan Mehmet Ozkok from Türkiye for pioneering work that combines AI and

water efficiency. By training artificial intelligence on the sound of leaking water, Ozkok built and deployed two prototypes to detect leaks in public spaces. Tested under real conditions, the prototypes demonstrated significant water savings and are now being developed further in collaboration with local government for possible city-wide implementation.
The Jury stated: “This year’s Diploma of Excellence recognizes how data, AI and action come together. Training AI based on the sound of leaking water, this student has demonstrated a powerful and practical approach to tackling urban water loss.”
People’s Choice Award –United Kingdom
The People’s Choice Award, voted on by the global public, went to Divyasri Kothapalli from the United Kingdom for her project, sun-based water distillation system.
This research project presents the development of a low-cost solar water distillation system designed to improve access to clean drinking water in off-grid and
rural communities. Using a Fresnel lens to focus sunlight onto a metal boiling pot, the resulting steam passes through foodgrade silicone tubing and condenses into clean water. The system operates without electricity, avoiding additional carbon emissions.
Kothapalli conducted three experiments where the independent variables included initial water volume, light intensity, and natural weather conditions. The system produced consistent yields even in moderate climates such as the UK, showing its promise for broader application.
A Year of Flood-Focused Excellence
This year, both Water Prizes highlighted flooding: the Stockholm Junior Water Prize went to German students Niklas Ruf and Jana Spiller for their innovative flood warning system, while the Stockholm Water Prize will be awarded to Austrian professor Günter Blöschl, the world’s leading flood hydrologist. Together, their work underscores the urgency of addressing flood risks – from local innovations to global science.
About the Stockholm Junior Water Prize
The Stockholm Junior Water Prize is an international competition for students between the ages of 15 and 20, encouraging innovative solutions to major water challenges. Every year, thousands of young people from more than 40 countries take part, with the national winners competing in the global final in Stockholm.
The Stockholm Junior Water Prize has been organized annually since 1997. It is hosted by the Stockholm Water Foundation, with Xylem as Founding Partner.
Niklas Ruf and Jana Spiller from Germany received the 2025 Stockholm Junior Water Prize for their scalable flood warning system for small streams. The award was presented by H.R.H. Crown Princess Victoria of Sweden at Stockholm City Hall during World Water Week. Jonas Borg
MASSACHUSETTS INSTITUTE OF TECHNOLOGY (MIT)
Palladium Filters Could Enable Cheaper, More Efficient Generation of Hydrogen Fuel
The novel design allows the membranes to withstand high temperatures when separating hydrogen from gas mixtures.
By Jennifer Chu
Palladium is one of the keys to jumpstarting a hydrogen-based energy economy. The silvery metal is a natural gatekeeper against every gas except hydrogen, which it readily lets through.
Palladium-based membranes are used at commercial scale to provide pure hydrogen for semiconductor manufacturing, food processing, and fertilizer production, among other applications in which the membranes operate at modest temperatures. If palladium membranes get much hotter than around 800 kelvins, they can break down.
Engineers at MIT have developed a new palladium membrane that remains resilient at much higher temperatures. Rather than being made as a continuous film, the new design is made from palladium that is deposited as “plugs” into the pores of an underlying supporting material. At high temperatures, the snug-fitting plugs remain stable and continue separating out hydrogen, rather than degrading as a surface film would.
The thermally stable design opens opportunities for membranes to be used in hydrogen-fuel-generating technologies such as compact steam methane reforming and ammonia cracking – technologies that are designed to operate at much higher temperatures to produce hydrogen for zero-carbon-emitting fuel and electricity.
“With further work on scaling and validating performance under realistic industrial feeds, the design could represent a promising route toward practical membranes for high-temperature hydrogen production,” said Lohyun Kim PhD ’24, a former graduate student in MIT’s Department of Mechanical Engineering.
Kim and his colleagues report details

of the new membrane in a study appearing in the journal Advanced Functional Materials. The study’s co-authors are Randall Field, director of research at the MIT Energy Initiative (MITEI); former MIT chemical engineering graduate student Chun Man Chow PhD ’23; Rohit Karnik, the Jameel Professor in the Department of Mechanical Engineering at MIT and the director of the Abdul Latif Jameel Water and Food Systems Lab (J-WAFS); and Aaron Persad, a former MIT research scientist in mechanical engineering who is now an assistant professor at the University of Maryland Eastern Shore.
Compact Future
The team’s new design came out of a MITEI project related to fusion energy. Future fusion power plants, such as the one MIT spinout Commonwealth Fusion Systems is designing, will involve circulating hydrogen isotopes of deuterium and tritium at extremely high temperatures to produce energy from the isotopes’ fusing. The reactions inevitably produce other gases that will have to be separated, and the hydrogen isotopes will be recirculated into the main reactor for further fusion.
Similar issues arise in a number of other processes for producing hydrogen, where gases must be separated and recirculated back into a reactor. Concepts for such recirculating systems would require first cooling down the gas before it can pass through hydrogen-separating membranes – an expensive and energy-intensive step that would involve additional machinery and hardware.
“One of the questions we were thinking about is: Can we develop membranes which could be as close to the reactor as possible, and operate at higher temperatures, so we don’t have to pull out the gas and cool it down first?” Karnik said.
The researchers looked for ways to improve the temperature resistance of palladium membranes. Palladium is the most effective metal used today to separate hydrogen from a variety of gas mixtures. It naturally attracts hydrogen molecules (H2) to its surface, where the metal’s electrons interact with and weaken the molecule’s bonds, causing H2 to temporarily break apart into its respective atoms. The individual atoms then diffuse through the metal and join back up on the other side as pure hydrogen.
Plugging In
Karnik, Kim and their colleagues took a different design approach. They observed that at high temperatures, palladium will start to shrink up. This gave the team an idea: If a supporting material’s pores could be “plugged” with deposits of palladium – essentially already forming a droplet with the lowest surface energy – the tight quarters might substantially increase palladium’s heat tolerance while preserving the membrane’s selectivity for hydrogen.
To test this idea, they fabricated small chip-sized samples of membrane using a porous silica supporting layer (each pore measuring about half a micron wide), onto which they deposited a very thin layer of palladium. They applied techniques to essentially grow the palladium into the pores and polished down the surface to remove the palladium layer and leave palladium only inside the pores.
They then placed samples in a custombuilt apparatus in which they flowed hydrogen-containing gas of various mixtures and temperatures to test its separation performance. The membranes remained stable and continued to separate hydrogen from other gases even after experiencing temperatures of up to 1,000 kelvins for over 100 hours – a significant improvement over conventional filmbased membranes.
Illustration of the membrane showing selective permeation of hydrogen (green) from a mixture of hydrogen and helium (blue) gases. Lohyun Kim
These conditions are within the range of hydrogen-generating technologies such as steam methane reforming and ammonia cracking.
Steam methane reforming is an established process that has required complex, energy-intensive systems to preprocess methane to a form where pure hydrogen can be extracted. Such preprocessing steps could be replaced with a compact “membrane reactor,” through which a methane gas would directly flow, and the membrane inside would filter out pure hydrogen.
Ammonia cracking is another way to produce hydrogen, by “cracking” or breaking apart ammonia. As ammonia is very stable in liquid form, scientists envision that it could be used as a carrier for hydrogen and be safely transported to a hydrogen fuel station, where ammonia could be fed into a membrane reactor that again pulls out hydrogen and pumps it directly into a fuel cell vehicle.
This work was supported by Eni S.p.A. via the MIT Energy Initiative.
ARIZONA STATE UNIVERSITY
Student Engineers Join Forces with Kenyan Communities for Clean Water
By Joe Kullman
Driven by the belief that access to clean water and reliable infrastructure can transform lives, Engineers Without Borders USA tackles complex challenges in communities around the world.
Through these efforts, a growing number of Arizona State University students are getting hands-on education in the technological, logistical, organizational and management skills needed to meet such challenges.
Among them are 22 members of the organization’s ASU student chapter who
are helping the East African nation of Kenya provide clean water to the rural village of Naki by designing, testing and implementing a water filtration system, funded in part by donation from ASU’s Change the World initiative and an ASU Global Education Office Go Global grant awarded to the Ira A. Fulton Schools of Engineering.
Over the past several semesters, successive groups of ASU students have contributed to the project in Kenya, a nation of more than 50 million people, each building on the work of the last. Last year, the ASU team helped restore a 20,000-gallon water tank, but after finding the water unsanitary, they developed a water filter using easily accessible materials like sand.
The team’s plans include implementing solar-powered well and rainwater catchment systems over the next two years to provide filtered water to as many as 2,000 people across three communities. A future well project will bring year-round access to clean water for more than 3,000 members of one community.
Engineer Jack Moody, a water resources services leader with Westwood Professional Services in Phoenix, and Jason Reynolds, a project engineer with Jett Civil Engineering based in Scottsdale, Arizona, serve as mentors for the ASU Engineers Without Borders chapter and have been guiding the students on their work for the Kenya project.
Moody pointed to the students’ exemplary work in helping construct a 70,000-liter, in-ground storage tank to collect water from rooftop runoff collection systems, repairing two earthen dams, and building a hydraulics laboratory at the Jaramogi Oginga Odinga University of Science and Technology in Kenya.
Community members in Kenya expressed appreciation for the students’ role

t A team of Arizona State University students poses with a scalable water filtration system they built for a secondary school in Naki, Kenya. The ASU student chapter of Engineers Without Borders, an international community service organization, contributed significantly to the project, along with another vital water infrastructure project in Kenya. Engineering Without Borders, ASU chapter
in strengthening local infrastructure and access to essential resources.
“The collaboration between ASU’s Engineers Without Borders chapter and local communities in Kenya has demonstrated the profound impact of student-led engineering initiatives on global development,” said Noah Okidia, a community volunteer partner in Kenya. “As a volunteer working with the ASU team, I have witnessed firsthand how technical expertise, coupled with cultural exchange and community engagement, can generate lasting solutions. Despite our vastly different cultures, the ASU Engineers Without Borders team has always fit into our communities and carried out their planned projects.”
These pursuits not only expand students’ engineering knowledge and problem-solving skills, but also give valuable experience in working with people from other cultures, said team leaders.
THE UNIVERSITY OF ARIZONA
Researchers Developing Water Reuse Solutions for Military and Civilian Communities
By Leslie Hawthorne Klingler
University of Arizona’s Water and Energy Sustainable Technology Center’s (WEST) expanding partnership with the U.S. Army Engineer Research and Development Center (ERDC) is driving new research on practical water reuse solutions for both military and civilian communities. “Water reuse is, of course, an important response to water scarcity,” said Andrea Achilli, principal investigator for two of the center’s largest current grants, “but we can’t forget it’s also about national security.”
Achilli, associate professor of chemical and environmental engineering, leads the U of A’s work in a four-year, $38M ERDCfunded Water Reuse Consortium – which also includes the University of Southern California and the University of Nevada–Reno. The U of A’s $10M portion of the grant supports research on smart treatment systems, sustainable brine management technologies, and improved virus

detection. It also invests in training and public engagement to encourage wider adoption of water reuse.
In 2024, the U of A and ERDC strengthened ties further by signing an Educational Partnership Agreement, enabling WEST to host postdoctoral researchers at its facilities. The first to participate, Luke Presson – an ORISE scientist with the Army Corps of Engineers – conducts research and connects partners across the Consortium to align its work with military needs. "This partnership shows how the federal government and universities


can work together to advance the research and better the nation. Using both of our strengths we can accomplish so much more than going at it alone. We hope this EPA is an example that we can replicate at other universities," said Nicholas Josefik, Presson’s supervisor at the U.S. Army Engineer Research Development Center.
One area of investigation where Achilli and Presson see big potential benefits is moving communities from massive water and wastewater treatment plants to smaller, mobile and semi-mobile advanced water purification systems. Traditional facilities are costly, built to last decades, and risky to upgrade. In contrast, decentralized systems are easier to adapt. For forward operating military bases, onsite reuse – particularly processes using
only electricity, without chemicals – could reduce the dangers of resupply missions. For civilian communities, these smaller systems would lessen dependence on large, centralized plants that leave entire communities vulnerable if they fail.
These concepts have already been put to the test through an earlier ERDCfunded effort, the ESTCP Demonstration Project. Completed in 2025, the project piloted a semi-portable, containerized advanced water purification unit.
The system performed well during trials at WEST and Tucson’s Tres Rios Water Reclamation Facility, but when deployed to Fort Huachuca it clogged due to excess solids in the water. Presson said the challenge was disappointing, but they were glad it showed up during testing.
“It’s better to find out that the system needs a simple mechanical screen before it’s sent to a forward operating base that’s relying on it to work,” he said. “That’s why what WEST does is so important.”



Andrea Achilli (left) and Luke Presson (right) at the ESTCP Demonstration Project semi-portable, containerized advanced water purification unit.
UNIVERSITY OF CHICAGO
Bio-Inspired Membrane Opens New Possibilities for Water Purification, Extraction
Taking lessons from biology, UChicago researchers develop system that controls chemical transport at atomic scale.
By Paul Dailing
In every living cell, there are membranes – and in every membrane there are proteins, each of which acts as a chemical gatekeeper.
Rather than passively letting ions pass in and out of the cell, these biochemical bouncers control access as needed. They let more of life-sustaining materials like potassium or sodium through the cells’ biological ion channels when the cell needs them but shut off the flow before the chemical concentration gets too high.
“It will advance technology greatly if we can understand ion transport in biological systems and creatively manipulate it in artificial ones,” said Asst. Prof. Chong Liu, of the University of Chicago Pritzker School of Molecular Engineering (UChicago PME).
This is a process biologists have studied and engineers have envied for years. The ability to tune membranes to let more of a material in sometimes and keep them out at other times could revolutionize how people make water safe to drink and remove harmful – or valuable –chemicals from oceans, lakes and rivers.
“Naturally, it becomes of interest to see whether you can build artificial systems that would, in some way or another, mimic those biological properties,” said Northwestern University chemistry Prof. George Schatz.
UChicago PME and Northwestern teams are behind a new paper in Nature Communications that both solved this mystery and revealed new insights into ion transport.
By using advanced simulations, the teams added different amounts of lead, cobalt or barium ions and found they could vastly increase or limit the amount of potassium passing through an artificial membrane – mimicking cells’ abilities to
mind their own biological membranes. Among the team’s more remarkable findings was that just a 1% increase in the presence of lead ions doubled the amount of potassium coming through the channels.
John Zich

“The most exciting part of our research is that we show how dramatically ion transport in angstrom-scale 2D channel can be changed in the presence of other ions, even with a tiny fraction,” said cofirst author Mingzhan Wang, who was a postdoctoral researcher in Liu’s UChicago lab at the time of the research and is now a research assistant professor at City University Hong Kong.
The research represents an advance in pure science, helping physicists and biologists understand better why ions and cells behave the way they do.
Opening the Door
Ion transport channels are exactly what they sound like – tunnels for ions.
In cells, these nanoscale tunnels run through the cell membranes; in devices, through plastic filters or other membranes. Positive charged potassium plods slowly through the negatively charged tunnel used in the present study, while negative charged chloride, ions containing the element chlorine, zip past.
Wang and Liu conceived the project and connected with Schatz through the Argonne-led Advanced Materials for Energy-Water Systems Center, which also funded the research. The mechanism behind it was not clear until co-first author Qinsi Xiong, a research associate in Schatz’s theoretical group, built an entirely new model from the ground up – in Schatz’s words, “from scratch.”
“We designed a non-equilibrium molecular dynamics simulation to incorporate an ion-induced dipole interaction and simulate ion transport through this 2D nanochannel,” Xiong said. “Our results aligned well with the experiments, suggesting that the physics we included were on the right track.”
Ions have either a positive or a negative charge, which means that any charged at-
t Researchers led by UChicago Pritzker School of Molecular Engineering Asst. Prof. Chong Liu and Northwestern University Prof. George Schatz have developed a tunable system that mimics cells’ abilities to mind their own biological membranes.
oms or molecules in the ion channel walls will push or pull on the travelers.
But when lead ions are added, those ions bond to acetate groups in the tunnel walls. The positively charged lead ions pull on the negatively charged chloride – not enough to stop the chlorides, just to slow them down to the potassium ions’ speed.
Once the chlorides and potassium ions are moving through the tunnel at the same rate, they form potassium chloride pairs. These are neutrally charged and so flow unimpeded through the channel, increasing the amount of potassium coming through the membrane.
“There’s nothing charged that it wants to interact with, and so that makes it so that the new molecule can flow through quicker than would occur if the two ions were just separately flowing through the channel,” Schatz said.
Cutting Off the Flow
The team also discovered an inhibitory effect, meaning a way to limit rather than enhance the potassium flowing through the channels. When they added small amounts of cobalt or barium ions, those metallic ions competed with lead ions for spots where they could bond to the acetate groups in the tunnel walls. This limits the effect of lead on these ions, and at the same time, reduces formation of neutral ion pair that would otherwise enhance transport.
The next steps for the research include seeing what other materials than lead can generate this effect, and if it can be expanded to control the flow of elements rather than potassium. One target would be lithium, valued for its use in batteries but currently harvested from water through environmentally damaging methods.
Funding: This work is supported by Advanced Materials for Energy-WaterSystems (AMEWS) Center, an Energy Frontier Research Center funded by the U.S. Department of Energy, Office of Science, Basic Energy Sciences.

October 27-29, 2026
Minneapolis Convention Center Minneapolis, Minnesota
Step Into the Spotlight at FiltXPO™ 2026
FiltXPO™ 2026 is where breakthrough filtration technologies, industry leaders, and new business opportunities converge.
Whether you’re looking to showcase your innovations or discover the next big thing, FiltXPO is where filtration moves forward.
Why Exhibit at FiltXPO?
Grow your business by connecting with decision-makers across diverse industries who are actively sourcing advanced filtration and separation solutions.
• Engage with 1,200+ filtration professionals from around the world
• Expand your North American market reach
• Generate leads across high-impact sectors, including:
• Automotive & Aerospace
• Biotech & Pharmaceuticals
• Food & Beverage Production
• HVAC & Indoor Air Quality
• Water & Wastewater Treatment
• Power Generation, Oil & Gas, and more
Minneapolis offers direct flights from major international and domestic cities, making it the ideal location to meet top-tier prospects.
Reserve your space on the show floor today and make your mark at FiltXPO 2026.

INNOVATION IN ACTION Filtration for Today ... and tomorrow
Filtration industry companies are investing in research and development to bring new ideas to the world for enhanced filtration solutions. Innovation requires intentional changes to generate long-term social and environmental benefits and improve the quality of solutions.
Innovations range from efficiency and effectiveness in design, durability and attributes, to responsible sourcing with materials that are bio-based or feedstocks that draw on regenerative, and/or sustainable agriculture principles to advance circularity; to advancements that extend product life, and more. Needless to say, the supply chain is changing, and offering up new and improved solutions.
We asked companies to submit their most recent advancements and we are pleased to highlight the following companies and their achievements.
COMPILED BY CARYN SMITH, CHIEF CONTENT OFFICER & PUBLISHER, IFN
A Unique Solution to the Die Cut Problem in HVAC Filters
The HVAC filter industry has long relied on die cut frames to meet the diverse needs of customers. These filters are available in a wide range of sizes and variants, tailored for specific applications across residential, commercial, and industrial environments.
However, this very diversity creates significant challenges for filter manufacturers.
The Manufacturing Challenge
Producing HVAC filters with die cut frames involves:
• Managing a large variety of die cuts to match product dimensions.
• Printing unique branding and specifications for each size.
• Carrying high inventory costs for die cut frames.
• Coping with long changeover times on the shop floor.
• Coordinating multiple independent processes such as frame making, pleating, assembly, and packing – each of which creates additional inventory, manpower needs, and risks of rejection.
• Relying on a large workforce to keep production running smoothly.
In short, the traditional approach is labor-intensive, costly, and inflexible.
What Manufacturers Want
Filter producers have been clear about their needs. They are looking for:
• Higher productivity
• Minimal human intervention
• Quick changeovers and greater flexibility
• The ability to cover a wide size range (10” to 30” filters, pleat heights of 1”, 2”, and 4”)
• Compatibility with both laminated wire-backed media and self-supported media
• A cost-effective solution that reduces waste and improves efficiency
A2Z’s Solution: The HVAC Production Line
Recognizing these challenges, A2Z’s design and product development team set out to reimagine the process. The result is a fit-to-purpose production line that combines flexibility, efficiency, and cost-effectiveness
– the A2Z HVAC Production Line
This innovative system streamlines filter manufacturing with just three inputs:
1. Filter media
2. Side frame and top/bottom band material in rolls
3. Hotmelt glue
With this simplified approach, manufacturers gain full flexibility to produce a wide range of filters without the burden of managing hundreds of die cut variants.
The A2Z HVAC Production Line: A Streamlined Workflow

The production process is designed to minimize complexity while maximizing efficiency. Starting with laminated or self-supported media, the system automates pleating, framing, cutting, assembly, and finishing – all the way to boxing the final product.

A Smarter Way Forward
The HVAC industry is under constant pressure to balance customer expectations with operational efficiency. With the A2Z HVAC Production Line, filter manufacturers finally have a solution that addresses both – reducing costs, streamlining workflows, and empowering them to adapt quickly to market needs.
In an industry where flexibility is key, A2Z has delivered a unique, cost-effective, and efficient solution to the age-old die cut problem.
For further information, please visit
• Our website – www.a2zfiltration.com
• Or contact us at corporate@a2zfiltration.com

Automated HVAC Filter Production Line – From media decoiling to packing, the process ensures precision, reduced labor, and consistency across every filter produced.
Redefining Filtration Intelligence: FA-TCO Software Evolves with Real-Time IoT Monitoring
and ASHRAE 52.2-Standardized Performance

In an industry where assumptions still guide filter replacement and performance expectations, FA-
TCO Software continues to redefine HVAC filtration management through standards-based intelligence and real-world data. Recognized as a 2025 FiltXPO™ Awards finalist, the software has now taken a major leap forward by integrating real-time IoT monitoring across pressure, flow, and particle metrics – closing the gap between theoretical performance and field reality.
FA-TCO is the result of over 35 years of technical development, built on a foundation of engineering excellence from the Universidad Simón Bolívar (USB) in Venezuela, with a track record of innovation in the oil & gas sector. This expertise later expanded into the U.S. filtration industry, contributing to cutting-edge advances in media formation and filter manufacturing technologies. Together, this dual legacy shaped a solution that bridges scientific rigor with industrial practicality.
From the beginning, FA-TCO has championed ASHRAE 52.2 as the cornerstone standard. Now in 2025, it enhances this commitment with embedded IoT sensors that bring continuous visibility into how filters perform – not just in the lab, but inside real HVAC systems.
The upgraded monitoring suite includes:
• Differential pressure sensors to detect clogging, bypass, or early degradation across filter stages.
• Airflow sensors to track actual system flow and fuel accurate TCO calculations.
• Particle matter sensors (PM1, PM2.5, PM10)
positioned after filtration, to monitor the true quality of air returning to occupied spaces.
This comprehensive monitoring architecture enables filter manufacturers, distributors, and facility managers to move from assumptions to measurable performance. FA-TCO now delivers live validation of filtration effectiveness, revealing trends in filter efficiency, early warning signs of failure, and IAQ results that matter.
Complementing this real-time view is a curated filter database – where each product is benchmarked against ASHRAE 52.2 test data at 492 CFM, ensuring every comparison is grounded in independent labtested values. This alignment enables users to detect performance gaps between certified expectations and real-world results, improving both decision-making and accountability.
Crucially, FA-TCO is not just about cost optimization. By focusing on air quality at the output of the filtration system, it guarantees that clean air is not only intended but delivered. This positions FA-TCO as both a TCO management engine and an IAQ assurance tool.
As environmental and performance standards grow more demanding, the HVAC industry faces increasing pressure to evolve. FA-TCO answers that call, empowering the sector to adopt data-driven filtration strategies that reduce waste, control energy use, and verify air quality with confidence.
Smart filtration is no longer optional. With FA-TCO, it’s measurable.
https://www.filtrationadvice.com
Next-Generation Filtration: Fibroline’s Expertise in MOF Functionalization
Fibroline is an engineering company based out of Lyon, France. With more than 50 patents worldwide, it is a world leader of ecofriendly impregnation technologies. It also has an innovation lab in the United States, in North Carolina. The company has developed dry powder impregnation solutions: this process uses high intensity alternating electric fields to enable the distribution of any form of powders into porous structures. Fibroline’s R&D team has unique know-how with dedicated knowledge for various sectors such as medical, filtration, composites or technical yarns.
In the filtration sector specifically, Fibroline has jumped on the emergence of a new material; Metal Organic Frameworks or MOFs. These are powders of controlled geometries composed of metal centers connected by organic linkers. They have a very large specific surface area (1700m2/g for MOF HKUST-1 for instance), extra-high porosity and highly adjustable pore size from microporous (< 2nm) to mesoporous (2-50nm).
These unique properties render them promising candidates for various high-tech applications: water treatment, gas adsorption, catalysis, drug delivery, dehumidification, etc. They are in fact created to target specific molecules: each MOF has a different structure for this purpose. The capacity of MOFs to pick molecules out is a real advantage in comparison to activated carbons, which are much less selective and therefore quickly oversaturated. MOFs can also realize several adsorption-desorption cycles: thanks to this, the media they are a part of does not require frequent replacement, thus increasing product lifetime.
Fibroline’s technologies are particularly suitable for the impregnation of MOFs to develop functionalized filter media. Indeed, by nature dry impregnation does not require any liquid binder, which results in the elimination of the clogging effect. Thanks to this, the active in powder form is made fully available and it all results in much higher overall efficiency of the impregnated products.
Fibroline has continuously grown its own expertise with these materials, and has developed impregnation processes for various types of MOFs. The company has worked on different types of filtration systems using MOFs such as carbon capture, gases capture, odor adsorption, and water depollution.
Fibroline has notably taken a significant part in large project involving several companies to develop several types of products. This project focuses first on a medical application to impregnate MOF for the capture of organosulfur gases present in ostomy pouches. It also aims to develop a military application with the impregnation of MOFs into foams, which will then become CBRN-suits’ linings, in order to capture war gases espe-


This illustrates the principle behind Fibroline’s technology, using alternating electric fields to impregnate materials.
cially organophosphorus gases such as sarin gas. These improvements lead to better protection for soldiers on the battlefield from all these risks.
For both of these products, present-day solutions use activated carbon. As mentioned earlier, activated carbon molecules are not as selective as MOFs. The use of MOFs-based solutions as those developed by Fibroline aims at greatly improving these products’ performances, and the results of these developments tend to prove the efficiency of MOFs compared to activated carbons.
This project highlighted significant number of potential applications for MOFs. There are indeed plenty of other topics to be explored for further developments. With the research on MOFs continuously growing, other innovations are to be expected. There will be opportunities for Fibroline to hop on, based on its unique technology and its expertise acquired over the years. https://www.fibroline.com

This picture depicts the HKUST-1 MOF, used for the capture of organosulfur gases.
Greentech Unveils 2025 HEPA Media with Embedded ODOGard® Technology: Revolutionizing
Clean Air Through Molecular Odor Elimination

In 2025, Greentech Environmental launched its most advanced filtration innovation to date: a nextgeneration HEPA media with embedded ODOGard® technology. Designed for highperformance air purification across commercial and residential applications, this breakthrough material redefines what HEPA filtration can achieve by combining ultrafine particle capture with molecular-level odor elimination.
The innovation begins with a self-supporting base media composed of ODOGard®-embedded fibers. This foundation is layered with an ODOGard®-infused nanofiber web and topped with a precision-engineered meltblown layer. Resulting in a composite HEPA media weighing just 140 gsm. Despite its lightweight structure, the media achieves a 99.98% particle capture efficiency at 0.26 microns while maintaining a low pressure drop of 130 Pa; a combination that ensures both superior air quality and energy efficiency.
“Our R&D team set out to create a media that would go beyond traditional HEPA,” said a spokesperson from Greentech’s product development division. “By embedding ODOGard® directly into the fiber matrix, we’ve developed a filter material that not only traps particles but chemically neutralizes odors and certain volatile organ-
Coolant/Metalworking Fluids Filtration, 3rd Edition – Technology Update
Coolant/Metalworking Fluids Filtration, 3rd Edition, Technology Update, is published by Joseph Market ing, and has 231 pages and 81 Illustrations which are single line drawings to guard against unwanted sales promotion for a specific equipment manufacturer.
As it did in the earlier editions, it covers closed loop filtration theory. Since there is a trend toward batch and smaller systems, progressive dilution and batch systems are also covered.
ic compounds (VOCs). This represents an entirely new level of clean.”
The result is a durable, sharp-pleating media suitable for a wide range of configurations – from compact filters with 7 mm to 55 mm deep pleat applications. The mechanical stability and uniform fiber structure enable high-volume manufacturing consistency while maintaining tight tolerances for performance-critical designs.
At the heart of the innovation is ODOGard®, a nontoxic, biodegradable, and water-soluble additive that forms a molecular bond with odor-causing compounds, permanently neutralizing them. This sustainable chemistry is embedded directly within the filter fibers during production, ensuring long- term efficacy without chemical off-gassing.
The industry has already taken notice: ODOGard® HEPA Media earned the Innovation in Air/Gas Filtration Award presented by INDA at FiltXPO 2025. The recognition underscores Greentech’s leadership in developing environmentally responsible solutions that merge performance, safety, and sustainability.
From hospitals and laboratories to hospitality and residential environments, this new HEPA media is poised to elevate air quality standards across industries. As the demand for cleaner, fresher, and safer indoor air continues to grow, Greentech’s innovation marks a significant leap forward in the science and sustainability of air purification. https://www.shopgreentech.com

The book has a glossary of terms, and a section devoted to typical points on general applications in the metalworking industry such as machining, grinding, rolling and wire drawing. Since portable and transportable cleaning devices are growing in popularity, a new section covers their use, as well.
Individuals who want to order the book should contact Joseph Marketing to get the specific shipping and handling cost. Payment can be sent in the form a prepaid check for the total amount. The book will be shipped immediately upon payment.
Single copy books are $40.00, plus shipping and handling.
Bulk orders for companies and corporations is available.
Joseph Marketing will invoice (could be proforma) for the books (at $40.00 each plus bulk handling and shipping).
Offshore sales will require a money transfer to the U.S. bank account of Joseph Marketing, and an extra fee will be added; or we can process checks drawn on a U.S. bank. Contact us directly for details on offshore sales. Quantity discounts are also available.
CONTACT:
Jim Joseph, Joseph Marketing, at Josephmarketing120@gmail.com or call (757) 565-1549
SEND CHECKS TO:
Joseph Marketing, 120 Richmond Hill Court, Williamsburg, VA 23185
For further assistance in filtration matters, Jim Joseph is available for consultation.
Advancing Sustainable Air Filtration: Lanaco Develops Patent
Pending 100% Biobased Pleatable Electrostatic Filter Media
Air filtration is evolving. While conventional synthetic materials have long met efficiency and reliability requirements, increasing regulatory pressure, sustainability expectations, and performance demands are driving the need for materials that do more than simply filter particles.
Lanaco’s patent-pending 100% biobased pleatable triboelectric filter media EcoStatic® provides a platform for the next generation of filtration. Designed to integrate into existing systems or form part of composite structures, EcoStatic® reduces reliance on fossilfuel-based materials and delivers performance that can surpass conventional filters. All EcoStatic® products are biobased and are registered with the USDA BioPreferred® Program.
EcoStatic® combines natural and biobased fibers chosen for performance. This performance specifically provides higher dust-holding capacity, lower airflow resistance, and longer operational life. The media is supported with innovative new materials to allow it to be pleated without compromising integrity. Airflow resistance ranges from 1 to 10 Pa per 100 g/m². Filtration efficiency for 0.3 μm particles is between 70 and 99.9%, depending on configuration. These properties enable more compact designs, reduce material use, and improve energy efficiency.
The media also contributes to the removal of VOCs, including formaldehyde, complementing or reducing the amount of activated carbon layers. Moisture man-

agement, water resistance, bacteriostatic properties, and intrinsic spark and flame resistance are achieved without additional chemicals. Such versatility has been proven in demanding applications, including for NASA astronaut breathing systems, demonstrating both robustness and reliability.
The product integrates easily with existing manufacturing lines while supporting new approaches to filter design. By incorporating EcoStatic®, companies can achieve differentiated, high-performing products that meet evolving environmental standards and sustainability goals. EcoStatic® delivers exceptional operational efficiency and extended service life. Its use supports net zero and nature-positive initiatives, enhancing brand credibility and demonstrating leadership in sustainability. The performance and environmental benefits provide clear value over conventional materials.
Lanaco positions itself not simply as a supplier but as technology partner with an added expertise and focus on sustainable materials. By collaborating closely with customer teams, the company helps shape advanced filtration solutions that combine high performance, functional versatility, and environmental responsibility.
EcoStatic® represents more than a material, it is a platform for innovation and a step towards transforming the air filtration industry through strategic, sustainable design.
For more information, visit https://lanaco.co.nz/.
Leanfil® — World’s Most Eco-Friendly Bag Filter
The history of Leanfil® bag filter begins with Samu Pöri and Tommi Lustig, the staff members of the Finnish air conditioning company Ilmastointipuhdistus PoLu Oy. When changing filters, they started to wonder why used filters and frames were always disposed of as mixed waste. If recycled correctly, the bag element should go to mixed waste and the frame, often made of galvanized steel, should be sorted as metal. At the same time, they wondered why frames in good condition must be disgarded as waste in the first place when users could use them several times.
In addition, Pöri and Lustig were frustrated by transporting large and heavy filter boxes to engine rooms and used bag filters to dumpsters and sorting stations. They concluded that the main reason for the problem was that because the frame could not be meaningfully detached from the filter element, the bag filter and the frame were always handled as a single unit.
Pöri and Lustig had a burning desire to develop the industry. They ultimately invented a new product for the bag filter market – a filter that could be detached from the frame and a frame that


could be used during the whole life cycle of the ventilation unit. The invention led to submission of a patent application and the start of the production process. This is how Leanfil ®was born.
The first part of the name, Lean, comes from the fact that the product saves raw materials, reduces waste, makes changing easier, and has been developed in accordance with the values and methods of Lean (continuous improvement). The last part of the name, fil, indicates filter.
So far, the product has garnered significant interest in the market and is already being sold in eight different European countries in addition to Finland.
For more information, email tommi.lustig@leanfil.fi or visit https://www.leanfil.fi/
Reemay® – Engineered for Superior Spot-to-Spot Uniformity in Filtration
By Saravanan Andan, Principal Engineer/Scientist at Magnera
In filtration technology, surface consistency is critical to achieving optimal performance, especially in highpressure or critical applications. Uniformity across the filter surface helps prevent weak spots, ensures consistent pore size distribution, and extends the lifespan of the filter. Reemay® PET spunbond has long been recognized as a premium material, extensively utilized in air, gas, and liquid filtration systems – either as a support layer or, in certain applications, as a filtration medium for capturing larger particles.
As filtration standards and regulatory requirements continue to evolve, the demand for consistent, spotto-spot uniformity in both filtration and support materials has become increasingly important. This article explores why uniformity matters and highlights the engineering advancements behind Reemay®’s superior consistency.
Why Surface Consistency Matters
A consistent filter surface ensures enhanced filtration efficiency by allowing uniform flow and particle capture. When the surface is uneven, thin spots with lower basis weight and larger pores emerge. These areas become weak spots with high permeability and low efficiency, allowing contaminants to pass through and compromising the filter’s integrity. Conversely, thick spots with higher basis weight and smaller pores result in low permeability and high efficiency – but also cause high pressure drops, which can strain the system and reduce throughput.
Uniform pore size distribution is essential for achieving optimal and consistent filtration performance. Filters with uneven pore structures may fail to retain particles effectively or clog prematurely. In high-pressure applications, such inconsistencies can lead to catastrophic failure, especially if weak spots rupture under stress. By maintaining surface uniformity, filters distribute pressure evenly, extend their lifespan, and avoid sudden breakdowns.



Engineering Uniform Spunbond Fabrics
Spunbond nonwoven fabrics are valued for their strength and versatility, but achieving uniformity requires precise control over multiple process variables. Improvements in uniformity in Reemay® PET spunbond has demonstrated significant improvements in uniformity – both visually and through quantitative testing –compared to standard spunbond webs1
Key variables that influence spunbond fabric uniformity include:
Fiber Cross Section - Trilobal fibers, compared to round ones, offer better coverage and distribution, reducing thin spots and improving filtration consistency.
Fiber Size - Adjusting spinneret hole sizes and draw ratios allows for better control over fiber diameter, which directly affects pore size and basis weight.
Electrostatics - Applying sufficient electrostatic charge helps spread fibers evenly during laydown, minimizing clustering and gaps.
Swath Width - Optimizing the width of the fiber swath ensures even coverage across the web, reducing variability from edge to center.
Laydown Air/Water Spray and Suction HandlingEffective air flow management and adequate suction are critical to holding fibers in place during formation. Poor suction can lead to fiber displacement and uneven layering.
Throughput - Lower throughput allows for more controlled fiber deposition, enhancing uniformity and reducing the likelihood of thin or thick spots.
Multiple Beams - Using multiple beams improves fiber layering and distribution, resulting in a more consistent web structure.
Results
Significant improvements in uniformity have been achieved by optimizing these variables. The table below shows the variations in a standard 25 gsm spunbond Reemay® and high uniform Reemay®. The uniform Reemay®



material clearly shows significant improvement in spot to spot thickness, air perm and basis weight uniformity.
The spunbond images on the previous page show the difference between standard Reemay® and Uniform Reemay® visually in two different basis weights.
Microban International - AkoTech™
A Sontara®’s EcoRE bags received the IDEA® Long-Life Achievement Award at IDEA®25, the premier global event for nonwovens and engineered fabrics.
Conclusion
Achieving consistent spot-to-spot web uniformity is essential for effective performance across a wide range of filtration applications, including both air/gas and liquid systems. Through optimization of process variables, substantial web uniformity in Reemay® was achieved. These improvements were clearly evident in both visual inspections and quantitative uniformity assessments, showing significant advancement over conventional spunbond webs. Magnera’s future efforts will focus on further refining these advancements to meet evolving filtration demands. https://magnera.com
koTech™ is a platform of multifunctional coating technologies that deliver advanced surface protection across a wide range of end-use products. Unlike single-function coatings, AkoTech is engineered to combine multiple desired attributes, such as PFAS-Free, antimicrobial performance, wash durability, adhesion and chemical resistance, into a single, customizable solution.
By integrating Microban’s antimicrobial expertise into advanced coating systems, the company created solutions that simplify formulation while allowing partners to address specific performance needs. AkoTech is available in both water-based and solvent-based versions, and supports multiple formats:
• Starting-point formulations (used as is or customizable)
• Ready-to-use formulas (require no additional formulation)
• Liquid concentrates (dilutable with water)
Because AkoTech is offered in pre-formulated or dilute/ concentrate forms, it can slot into existing coating lines (spray, roll, dip, etc.) with minimal process change.
Core performance features include enhanced wash durability, water and oil repellency, environmental odor capture and chemical resistance. The technology is heavy metal-free. Coating developers can fine-tune properties depending on the substrate (polyester, polypropylene, glass, etc.) and desired balance of performance features.
In trials, select formulations demonstrated up to 99.99% reduction in microbial colonization on coated surfaces, while maintaining durability after chemical exposure and repeated cleaning cycles. These results support that AkoTech can extend product lifetimes and maintain appearance under demanding conditions.
AkoTech can be provided in both water-based and solventbased solutions to meet different manufacturing requirements

and can be applied to a wide range of filtration substrates and enduse applications, including:
• HVAC Units
• Automotive Air Cabins
• Air Purifiers
• Face Masks
AkoTech represents a leap forward in filtration finishes, delivering multifunctional performance under a modular, brand-friendly platform. As industries demand smarter, longer-lasting surfaces, AkoTech gives manufacturers a compelling tool to deliver on both technical excellence and market differentiation.
For more information, visit https://www.microban.com/ coatings/technologies/akotech or email info@microban.com.
AkoTech mode of action image, showing how the technology is integrated and how the treated product remains cleaner.
MAGNERA
t Left: Fungal Growth covering untreated filter. Right: Akotech Treatment protecting the filter from fungal growth.
Moeller Continues to Innovate

Polystyrene frame classified F1 based upon DIN 53438-3 and can be operated long term up to 120° C (248° F).
Moeller GMBH & Co. KG located in Eversberg, Germany operates 29 extrusion lines for producing among other things high-quality plastic profiles for the air filter industry. Moeller has historically offered a wide range of filter frame systems made of high impact polystyrene or ABS. After years in development, Moeller has recently been able to consistently prove the process for both extruding and injection molding a proprietary high-temperature resin.
While our standard polystyrene frames carry a fire classification of F2 based on DIN 53438-2 and can be operated long term up to 70° C (158° F), this recently introduced high-temperature version is now classified F1 based upon DIN 53438-3 and can be operated long term up to 120° C (248° F).
Early on Moeller’s development of double wall extruded profiles allowed their filter framing systems to
Filter Design Is Enhanced by Flow Imaging
By Wen Liu
Reaching net-zero emissions by 2050 requires enhanced filtration systems designed for specific operational needs. Pall Corporation collaborates with customers in many sectors to provide tailored solutions that improve performance and sustainability. At the heart of this is a strong filter design value chain that includes material selection, element structure, housing design, and thorough testing, all backed by focused research and development.

CT scan of pleats in cross-sectional view, with flow paths between pleats highlighted by deposited BaSO4 particles.
To meet high standards for efficiency, durability, and environmental impact, it’s important to understand how fluids interact with filter media, flow through elements, and distribute across systems. Traditional methods, which rely on upstream and downstream sampling, often overlook the complex internal dynamics of filtration. Advanced flow imaging technologies, such as computed tomography (CT) and nuclear magnetic resonance (NMR), address this gap by providing real-time, non-invasive views of fluid behavior within filters. These tools support detailed analysis and optimization throughout the design process.
One important application is multi-phase fluid detection, which is vital in decarbonization processes such as carbon capture and hydrogen purification. For instance, Pall’s coalescers separate immiscible fluids by merging droplets for easier removal. NMR imaging can differentiate between gas and liquid phases in packed beds with micron-level detail, offering useful insights for filter design and operational adjustments. Flow imaging is also versatile across different media formats. For fibrous media, magnetic resonance techniques show fluid

exceed most industry requirements for strength and stability. Now with the added feature of an increased thermal operating range, these frames have become a viable option to replace conventional filter frame components such as steel, aluminum and wood products. This development has already been proven to be a viable replacement for certain HEPA filter frames which have historically used metal components. While there has been a benefit in pricing, customers site the key advantages as the ability to incinerate the product as opposed to landfilling and the ability to construct a significantly lower weight finished product while still maintaining the structural requirements for the application. Moeller continues to be committed to the use of reclaimed and recyclable materials free from halogens, CFC's, silicones and heavy metals. To learn more about Moeller go to www.moeller-profilsysteme.de

distribution and contaminant saturation. In hollow fiber modules, these methods create velocity maps to evaluate performance. CT scans are ideal for analyzing pleated flat-sheet media. When combined with contrast agents like BaSO, CT imaging highlights flow paths and manufacturing results, guiding pleat optimization for specific decarbonization needs.
Finally, flow imaging provides a broad view of fluid distribution across entire filters. This overall perspective helps to identify stagnation zones, turbulence, or uneven flow that can hinder efficiency. Visualizations using color-coded flow fields can identify bottlenecks and direct design improvements to ensure even flow and minimal energy loss.
By integrating advanced imaging into every stage of filter development, Pall leads the way in creating high-performance filtration solutions that support global decarbonization goals. These technologies offer the clarity and precision required to design filters that are not only effective but also sustainable. https://www.pall.com

Wen Liu is a Scientist II in the Filtration Technology team at Pall Corporation. She received her Ph.D. in Chemical Engineering from University of Texas at Austin, where her research focused on nanomaterials and renewable energy applications. At Pall Corporation, Wen leverages her expertise in computational fluid dynamics and flow visualization testing to develop innovative filtration solutions that enhance performance and advance sustainability efforts.
PALL
SinterPore® HD Erosion Resistant Filter System
Erosion-resistant filters are critical components in systems exposed to high-velocity, particle-laden fluid streams. These filters are engineered to maintain structural integrity and filtration performance under conditions that typically induce rapid wear in conventional materials. Applications such as oil and gas production, mineral processing, water treatment, and HVAC systems often involve abrasive flows – containing particulates like sand, dust, or other contaminants – that accelerate material degradation. Erosion-resistant filtration media mitigate this by reducing material loss, extending service intervals, and improving system reliability.
Beyond mechanical protection, these filters support process stability in fluid and air handling systems by preserving filtration efficiency despite sustained abrasive loading. Consistent performance is essential for maintaining compliance with environmental and quality standards, particularly in regulated industrial sectors. Additionally, the reduction in unplanned maintenance and component replacement contributes to overall system uptime and operational cost efficiency.
From a sustainability standpoint, erosion-resistant filters reduce lifecycle material consumption and waste generation. By extending usable life and minimizing the frequency of replacement, they contribute to more resource-efficient operations.
Porous Metal Filters Inc. (PMF) has developed SinterPore® HD; an erosion-resistant, diffusion-bonded filter system featuring an advanced surface coating that provides up to 8 times greater erosion resistance compared to conventional 316 stainless steel mesh. The applied coating – averaging 18 microns in thickness – enhances wear resistance without compromising pore geometry or permeability.


The use of multi-layer woven metal mesh laminates supports precise particle retention, uniform flow distribution, and increased structural integrity under pressure. Standard configurations include two- to fourlayer laminate constructions, which can be customized based on application-specific flow, pressure, and particulate requirements.
Material selection includes fully annealed corrosionresistant alloys such as 316L stainless steel and Alloy 20, enabling deployment in chemically aggressive or hightemperature environments and with the additional coating, highly erosive environments. Filtration ratings are available in the 60 μm to 1,000 μm range, with custom micron ratings and laminate constructions available to accommodate non-standard operating parameters. Visit our website www.pmfilter.net.
W.H. Kingsmill Ltd.: Precision in Filtration – Innovating Leak Detection with Dust Chaser
In industrial filtration, maintaining optimal efficiency and preventing costly downtime are paramount. Undetected leaks in dust collection systems are a significant contributor to decreased performance, increased energy consumption, and potential environmental and safety concerns. At W.H. Kingsmill Ltd., we are directly addressing this critical industry challenge with our innovative, high-temperature Dust Chaser Fluorescent Leak Detection Powder, which is used for inspection of fabric filter dust collector systems.


With over five decades of specialized experience in industrial baghouse applications, W.H. Kingsmill's expertise is deeply rooted in providing solutions that not only diagnose existing problems but proactively prevent future ones. Dust Chaser embodies this preventative philosophy. This advanced, non-toxic, and non-hazardous high temperature fluorescent powder is designed for straightforward application. When introduced into a dust collector, it effectively highlights leaks in filter bags, cartridges, seams, and tube sheets under ultraviolet light. This precise and efficient method serves as an indispensable tool for routine maintenance checks and new system commissioning,
ensuring immediate detection and rectification of issues for sustained peak operational efficiency. Our commitment to filtration innovation extends beyond leak detection. We also provide Guardian Precoat, an advanced filter bag conditioning agent that optimizes filtration performance from initial startup and extends the lifespan of filtration media. These specialized products, combined with the innovative ideas and technical knowledge of our team, enable us to assist customers with product application, system optimization, and best practices in filtration maintenance. This ensures our clients achieve superior performance and compliance.
W.H. Kingsmill Ltd. is dedicated to advancing the field of industrial filtration by providing high-quality, effective, and innovative solutions. Our focused approach to precise leak detection and comprehensive filter conditioning empowers our clients to maintain cleaner operations, reduce energy consumption, and significantly extend the service life of their filtration assets. We believe our contributions are vital in setting new standards for filtration integrity and efficiency in the marketplace. To explore the efforts of W.H. Kingsmill towards redefining excellence in filtration system maintenance and efficiency, visit www.whkingsmill.com
Erosion resistant coating can be applied on filters such as these.
Dust Chaser Fluorescent Leak Detection Powder.
Timilon Corporation’s EnviroKlenz SMARTView AQI
Timilon Corporation’s EnviroKlenz SMARTView
AQI is the next generation of indoor air quality management – an AI-powered platform already deployed across schools, transit systems, and commercial facilities to provide real-time monitoring, automated remediation, and defensible health benchmarks. The intuitive dashboard, paired with autonomous air cleaning and monitoring devices, goes beyond mere data collection to truly learn from environments and determine best practices for maintaining healthy occupant conditions.


Unlike other air cleaning platforms, EnviroKlenz SMARTView AQI integrates continuous monitoring with FAST-ACT® filtration technology, a breakthrough originally engineered for the U.S. Department of Defense and validated in demanding environments. This closed-loop system continuously detects harmful changes in indoor air quality, automatically triggering remediation events without relying on manual air cleaning intervention. From there, data-driven oversight and management take place on its cloud-based dashboard, creating an overall measurable, defensible, and scalable solution for buildings and homes. The interconnected system is already deployed across schools, transit fleets, and casinos, where thirdparty testing and customer data show reductions and improvements that have a significant impact on public health and productivity.
“EnviroKlenz SMARTView AQI was built to do more than track air quality – it was designed to understand it," said George Negron, Timilon’s SVP of Sales and Marketing. “Traditional dashboards only tell you what has already happened. SMARTView AQI goes further by

analyzing live patterns, predicting risks, and giving you the insights to act before the problem occurs”
EnviroKlenz SMARTView AQI is powered by one of the largest live IAQ sensor networks in the U.S., giving customers not only real-time insights but also compliance reporting, defensible benchmarks for audits, and early warnings that help avoid downtime, recalls, or liability. The system then uses this context to provide real time alerts, trigger filtration events, and guide users toward long-term solutions unique and personalized to their needs.
As highlighted in HealthBeat’s July 2025 article on school bus pollution, the IAQ platform’s EnviroKlenz SMART Mount™ air filtration hardware is already deployed by transit agencies including Delaware Transportation (DART) and Monroe Transit (LA), as well as public institutions like the Orangeburg School District, Wilmington University, Four Points Academy, and Penn Entertainment gaming casinos. In Michigan, EnviroKlenz SMARTView AQI is part of state funded projects analyzing IAQ in over 125 senior homes and 40+ high needs family residences to evaluate the impact of IAQ on both learning environments and agingin-place residency.
By targeting fine particulates (PM2.5), often used by EPA and CDC as a proxy for airborne pathogens, and volatile organic compounds (TVOCs) linked to trafficrelated pollution, the EnviroKlenz SMARTView AQI platform directly reduces health risks in the environments where exposure is highest. In a live school bus project in Atlanta, GA, we documented approximately 50% reductions in both PM2.5 and TVOCs within active school buses. Since children can spend one-two hours per day on buses, accounting for up to 80% of their daily exposure, these improvements translate into measurable gains for public health, reduced respiratory risk, fewer missed school days, and improved productivity for communities. In a public smoking casino, SMARTView AQI with the SMART Mount™ reduced PM by more than 70% and TVOCs by 89%, reducing secondhand smoke exposures that the CDC and Surgeon General directly link to heart disease, stroke, lung cancer, and respiratory illness. Taken together, these results demonstrate that SMARTView AQI not only drives compliance with EPA and OSHA standards but also delivers empirically proven improvements to health, safety, and operational outcomes in some of the most challenging environments. This innovation builds on Timilon Corporation’s legacy of safe, science-backed environmental solutions, now reimagined for autonomous, real-time protection in the spaces where people live, work, and breathe. Visit us at https://smartviewaqi.com/home
TIMILON

SYNERGIZING Clean Energy & Clean Air
A Strategic Framework for Filtration, Trade, and Sustainable Governance (LGR)
By Dr. Iyad Al-Attar, Global Correspondent for Innovations and Technology, IFN
In a significant move to bridge the critical discussions around global health and sustainable commerce, Dr. Iyad Al-Attar, IFN global correspondent, travels to Switzerland. There, he sits down with Mr. Ricardo Meléndez-Ortiz for an exclusive and illuminating interview. This timely interview aims to dissect the intricate connections between cutting-edge filtration technologies, robust Indoor Environmental Quality (IEQ) governance, and pivotal Environmental, Social, and Governance (ESG) metrics, all within the dynamic spheres of international trade, technological advancement, and long-term sustainability.
Indoor air quality is a vital matter in everyone’s daily life, yet it is often taken for granted or left unattended. Providing the best technologies and innovations to ensure proper indoor air quality requires that governments, industry, and stakeholders purposefully facilitate the rapid production and deployment of filtration equipment. The questions you raise highlight that critical areas of policy and governance must adjust and evolve to effectively deliver equitable, sustainable solutions that protect health, save lives, and contribute to a more livable planet.
Lessons from the past decade on clean energy technologies (CETs) highlight how much needs to be done and, more importantly, how feasible it is to achieve this by focusing efforts on sustainability principles and a multi-stakeholder approach.
Q+A

IN THIS ISSUE: MR. RICARDO MELÉNDEZ-ORTIZ Senior Advisor, Enlighten Advisory Switzerland
The urgent need to mitigate climate change has driven a rapid and massive scale-up of CETs globally, supported by international, national, and subnational policies. Years of experience in this work demonstrate how coordinated regulatory frameworks, trade facilitation, and investment incentives are essential for scaling technologies that address critical societal challenges. Similar approaches can inform international governance and regulatory systems for air filtration, ensuring equitable access, high-quality standards, and rapid deployment to protect human health and the environment.
Trade & Equity
Dr. Iyad Al-Attar: How can international trade agreements and regional policies be structured to ensure equitable access to advanced air filtration technologies for all nations, regardless of their economic development, while simultaneously preventing the dumping of substandard products that might exacerbate indoor air quality disparities in less regulated markets?
Mr. Ricardo Meléndez-Ortiz: International trade and regional agreements, along with their ensuing policies, could be key levers to ensure that advanced air filtration technologies reach all nations, regardless of their level of economic development, while preventing harmful outcomes such as the dumping of substandard products. Such dumping not only undermines fair competition but can exacerbate indoor air quality disparities in markets with weaker regulatory oversight, disproportionately affecting vulnerable populations.
To more effectively address this, cooperation at the international/global level could:
• Agree and mandate minimum quality standards and certification procedures for products crossing borders, ensuring that all exported filtration technologies meet rigorous performance criteria.
• Facilitate technology transfer and support capacity building in developing nations, enabling them to absorb, adopt, maintain, and verify high-
quality solutions rather than relying on cheaper, low-performing options that are often imported.
• Include enforcement provisions and monitoring mechanisms that hold exporters accountable and empower importing nations to reject substandard goods.
A critical first step involves compiling a comprehensive inventory of all key components of air filtration equipment and related goods that cross international borders. An inventory of all goods (from raw materials to complex components) using the harmonized tariff system (HTS) codes from the World Customs Organization (WCO) will then enable policymakers, jointly with industry, to identify comprehensive geographical organization and dynamics of supply chains, associated trade flows, disabling and enabling regulatory norms, as well as risks, including low-quality product proliferation.
Based on this analysis, policymakers may pursue targeted liberalization of high-quality filtration goods through the WTO’s Environmental Goods and Services negotiations or regional and bilateral agreements, while simultaneously embedding safeguards to prevent the entry of substandard products. Incentives such as technical assistance, export-import compliance support, and recognition for high-performing manufacturers can encourage the production and trade of reliable, safe, and effective filtration technologies. By combining liberalized access with robust quality enforcement, trade policy can rapidly expand the availability of advanced filtration solutions, reduce health disparities, and protect populations in less-regulated markets, all while promoting a more sustainable and equitable global indoor air environment.
Equality & Governance
Al-Attar: What specific regulatory frameworks and enforcement mechanisms are needed at local, national, and international levels to guarantee that all individuals, particularly those in vulnerable populations (e.g., low-income communities, schools in underserved areas, elderly care facilities), have equal protection
from indoor air pollutants through mandated minimum IAQ/IEQ standards and readily available, affordable air filtration solutions?
Meléndez-Ortiz: Protecting vulnerable populations – such as low-income communities, schools in underserved areas, and elderly care facilities – requires multi-level governance. At the local level, mandated IAQ/IEQ standards may be implemented/enforced through community-based monitoring programs, allowing residents and organizations to participate actively. At the national level, enforceable regulations may include compliance penalties and financial support to make high-quality filtration accessible. At the international level, harmonized standards can prevent regulatory arbitrage and establish minimum benchmarks for indoor environmental quality.
The clean energy experience emphasizes the need for predictable, coordinated rules across jurisdictions. Coordinated frameworks help prevent fragmented policies, enable scaling of technologies, and allow innovation to flourish without unnecessary trade disputes. Enforcement mechanisms should combine inspections, real-time monitoring, and public reporting, empowering communities to hold stakeholders accountable. All these measures ultimately aim to rapidly expand access to filtration technologies, thereby safeguarding human health and contributing to a more sustainable world.
ESG & Sustainability (Technology Focus)
Al-Attar: From an ESG perspective, how can investors and companies be incentivized to prioritize the development and adoption of air filtration technologies that not only demonstrably improve IAQ/ IEQ but also adhere to strict lifecycle sustainability principles, including minimal energy consumption, reduced waste generation, and the use of ethically sourced, recyclable materials?
Meléndez-Ortiz: Investors and companies can be incentivized from an ESG perspective to prioritize air filtration technologies that meet both performance and sustainability goals. Incentives could in-

clude tax benefits, public recognition, or ESG-linked investment criteria that reward innovations demonstrating:
• Performance: Measurable improvements in IAQ/IEQ.
• Lifecycle Sustainability: Low energy consumption, minimal waste generation, and use of ethically sourced, recyclable materials.
• Transparency: Clear reporting on environmental and social impacts. By focusing on these goals, investment and corporate strategies not only improve indoor air quality but also advance broader sustainability objectives, aligning with global goals such as reducing pollution, conserving resources, and protecting human health. The rapid expansion of these technologies is essential for saving lives, mitigating the health impacts of poor air quality, and making the planet more habitable for current and future generations.
Sustainability & Trade (Supply Chain Focus)
Al-Attar: Beyond the performance of the filtration technology itself, how can global supply chains for air filtration components and systems be made more sustainable and transparent, considering the environmental impact of raw material extraction, manufacturing processes, transportation, and end-of-life disposal, while also ensuring fair labor practices and responsible sourcing throughout the entire value chain?
Meléndez-Ortiz: Innovation is the primary driving force behind high-quality economic development, and the global value chain (GVC), with intermediate goods as
its carrier, is a crucial channel for international technology spillovers. As mentioned above, sustainability must extend beyond the performance of the technology itself to encompass the entire global supply chain. Key strategies include:
• Minimizing environmental impacts in raw material extraction, manufacturing, and transportation.
• Implementing recycling programs and responsible end-of-life disposal.
• Ensuring fair labor practices and ethical sourcing across the value chain.
• Embedding supply chain transparency and ESG compliance into trade and procurement agreements.
Much like CETs, air filtration supply chains need to benefit from harmonized regulations, predictable trade rules, and coordinated policy interventions. These measures would foster technology development, including through embeddedness of enterprise innovation, and simultaneously reduce the risk of environmental harm, promote fair labor policies and practices, and foster market growth.
Equity & ESG (Investment & Policy)
Al-Attar: What innovative financing models, public-private partnerships, and ESG-aligned investment strategies can be developed to drive significant, longterm improvements in IAQ and IEQ in existing and new buildings – specifically targeting historically underserved communities and ensuring that the benefits of cleaner indoor air are equitably distributed across society rather than becoming a luxury good?
Meléndez-Ortiz: Financing strategies must ensure equitable access to improved IAQ/IEQ, particularly for historically underserved communities. Innovative approaches include:
• Blended public-private funds and ESG-linked bonds targeting deployment in schools, healthcare facilities, and low-income housing.
• Public-private partnerships to subsidize high-quality filtration systems and support ongoing maintenance.
• ESG-aligned investment criteria that measure social outcomes alongside financial performance.
Lessons from clean energy show that policies and investments aligned with social and environmental goals can rapidly scale technology while ensuring benefits reach the communities that need them most. In today’s world, investors and financial markets are responding with institutions and instruments that make combining equity with sustainability a primary objective and principle.
Al-Attar: Beyond simply asking, “What do we want governments to do for us to ensure healthier indoor environments?”, shouldn’t the fundamental question also be: “How can governance models be reshaped to genuinely facilitate and prioritize robust community engagement, empowering individuals and local groups to actively participate in defining, monitoring, and enforcing the indoor environmental quality standards that directly impact their daily lives?”
Meléndez-Ortiz: Effective governance must actively empower communities. Participatory models could include:
• Local stakeholder input in defining IAQ/IEQ standards.
• Community-led monitoring with publicly accessible data.
• Mechanisms for residents to report non-compliance and request improvements.
Such approaches ensure that policies reflect lived realities, build trust, and enhance accountability. They also reinforce a broader principle: law and policy should be tools to advance justice, equity, and sustainability, just as they are in the transition to clean energy. Notably, community engagement accelerates the adoption of filtration technologies, enhances public health outcomes, and contributes to a more sustainable and livable planet.
Al-Attar: What are three key lessons that can be applied from global clean energy governance to create a more effective international framework for air filtration?
Meléndez-Ortiz: The global experience with CETs offers three key lessons for air filtration governance:
1. Coordinated international frameworks matter: Fragmented policies
slow adoption, create trade barriers, and limit equitable access. Harmonized standards, temporary waivers, or interpretive clarifications can provide predictability while respecting domestic policy priorities.
2. Market and policy incentives accelerate scaling: Tariff liberalization, regulatory clarity, and targeted subsidies have proven essential in clean energy. Similar incentives can promote the adoption of affordable, high-quality air filtration worldwide.
3. Balance enforcement with flexibility: Clean energy policies highlight the importance of predictability alongside flexibility – allowing innovation while minimizing trade disputes. Applying this principle to air filtration ensures rapid deployment without compromising standards or equity.
By borrowing these lessons, global governance for air filtration can both expand access and ensure that technologies contribute meaningfully to public health, as well as social and environmental sustainability.
Indoor air quality challenges illustrate the complex intersections of trade, technology, governance, and social justice. Lessons from international sustainable development law, trade policy, and clean energy governance show that integrated, multi-level approaches are essential. Laws and regulations must be coordinated across borders, financial and policy incentives must align with social and environmental goals, and communities must have meaningful input in decision-making processes.
By designing trade agreements that promote equitable access, implementing robust regulatory frameworks, encouraging ESG-aligned innovation, fostering sustainable supply chains, and empowering communities, we can create solutions that are sustainable, just, and effective. Rapidly expanding the use of air filtration technologies is essential not only for saving lives and protecting human health but also for building a healthier, more sustainable, and livable planet.

A Note From Dr. Iyad Al-Attar
When we think about improving the air we breathe indoors, the solution often seems simple: Buy an air purifier, plug it in, and you're done. This view treats clean air as a personal consumer choice, a problem that a single technological solution can solve. While high-quality filters are essential, this perspective overlooks the broader context. Ensuring clean, healthy indoor air
for everyone is not just a domestic issue; it's a complex global challenge that intersects with international trade, sustainable finance, and social justice.
As Mr. Meléndez-Ortiz indicated, the problem can feel overwhelmingly complex, but a roadmap for solving it may already exist. To tackle the global challenge of indoor air quality, we can draw powerful lessons from a seemingly unrelated field: the worldwide transition to clean energy. This global effort provides a

tested, actionable blueprint that can help us bypass years of trial and error in scaling up life-saving technology, aligning international policy, and ensuring that the benefits reach the most vulnerable populations. The path to a bright future filled with fit-for-purpose filtered air requires us to think beyond filter performance and embrace a more integrated, systemic approach, wherein all stakeholders acknowledge their responsibility in promoting sustainability.
Dr. Al-Attar is IFN’s Global Correspondent, Technology and Innovation, with insight as a mechanical engineer and an independent air filtration consultant. He is a Visiting Academic Fellow in the School of Aerospace, Transport, and Manufacturing at Cranfield University, consulting for air quality and filter performance relevant to land-based gas turbines. His expertise is on the design/performance of high-efficiency filters for HVAC and land-based gas turbine applications, focusing on chemical and physical characterization of airborne pollutants. Dr. Al-Attar is also the strategic director, instructor, and advisory board member of the Waterloo Filtration Institute. In 2020, Eurovent Middle East appointed Dr. Al-Attar as the first associated consultant for air filtration, as well as an Indoor Air Quality (IAQ) patron for EUROVENT.

CLARITY YOU CAN COUNT ON.


Compiled By Dr. Iyad Al-Attar
A Former Teacher's Mission: Making Clean Air a Reality in Schools

The pandemic revealed how truly vulnerable and unprepared schools were, and are, to protect against airborne threats. School closures disrupt learning and deepen inequities. Having an Indoor Air Quality (IAQ) plan in place is essential "shutdown insurance." By creating and implementing effective IAQ plans, schools can become better equipped to manage the next crisis, whether from an illness outbreak or smoke from wildfires.
Poor indoor air quality disproportionately affects low-income communities, where aging infrastructure and limited resources compound health risks. Students in underfunded schools are more likely to suffer from asthma and chronic absenteeism, conditions hindering academic achievement and widening opportunity gaps.
Meaningful and sustainable change requires intentional planning. Implementing comprehensive IAQ plans shifts school districts from reactive fixes to proactive solutions, protecting occupant health and improving learning outcomes.
The return on investment for IAQ improvements is substantial. The benefits include better attendance and higher test scores for students, reduced healthcare costs, and increased teacher retention. Even modest upgrades, like improved filtration and ventilation, bring measurable fiscal gains. Lisa's vision is simple yet profound: healthier schools, empowered communities, and a future where indoor air quality is no longer invisible.
Through her digital outreach, Lisa shares information and videos on the importance of
air quality, continuing her mission to ensure clean air is not a privilege, but a right for everyone. And by implementing an IAQ plan, schools can protect students, empower educators, and ensure that learning occurs safely and effectively in an inclusive classroom. Simply put, better air quality in schools equals better outcomes for everyone.
About Lisa Greenfield, CAFS. Lisa Greenfield, CAFS, the Midwest Regional Program Manager with the Center for Green Schools at USGBC, is a powerful advocate for improving Indoor Air Quality (IAQ) in schools. With 20 years of experience as a public school and early childhood educator, she brings firsthand knowledge to her commitment: making clean air a cornerstone of student and staff health.
The Invisible Wall: How Buildings Can Trap or Tame Pollution

Air quality is a critical global concern with significant economic and health implications, contributing to millions of premature deaths each year. Addressing this multifaceted issue requires a holistic, interdisciplinary approach, in which architecture plays a pivotal role.
While policy efforts focused on reducing vehicular emissions are essential, they are insufficient on their own. The design of human settlements must consider all scales – macro, meso, and micro – as local air quality can vary dramatically over short distances. These variations are influenced by factors such as urban structure, density, topography, and microclimatic conditions, including temperature, humidity, and wind patterns.
A key strategy for mitigating pollutant concentrations is ventilation. However, this
approach presents a challenge: has the relationship between land uses across different municipal and regional boundaries been adequately evaluated? Suppose prevailing winds carry pollutants from industrial or high-traffic areas. In that case, they can transport these contaminants toward sensitive receptors, such as healthcare facilities, schools, and residential communities, undermining the very purpose of a ventilationbased solution.
Buildings are often designed to enhance ventilation for passive cooling and to remove indoor pollutants. However, this strategy faces several challenges. What happens if the air being drawn in comes from a polluted outdoor environment? Furthermore, the materials used in a building's construction, as well as its furniture and decorations, can themselves be sources of indoor air pollution. These materials can emit volatile organic compounds (VOCs) and other harmful substances, which can then be trapped inside. As these materials age and degrade, do these emissions change?
We are constantly exposed to numerous sources of indoor air pollution, often without realizing the long-term effects they can have on our health and the health of our families. Therefore, it is crucial that we consider all potential sources of pollution, both internal and external, when designing and constructing buildings.
Finally, since pollutants can interact with one another and reinforce individual processes, airborne particles, their sources, and their interactions, as well as the impact on public health, must be considered. Furthermore, awareness campaigns are necessary to inform the population about potential risks and how they can be mitigated.
About Dr. María del Mar Barbero Barrera. María del Mar Barbero Barrera (ORCID: 0000-0002-4605-3154) is a PhD architect and Associate Professor at the School of Architecture (ETSAM) of the Universidad Politécnica de Madrid (UPM), in the Department of Construction and Technology for Architecture (DCTA). Her research addresses sustainable construction, building materials and construction systems. Her investigation has been disseminated in more than 45 papers in scientific journals and more than 50 papers in international congresses. She has
Lisa Greenfield, CAFS
Dr. María del Mar Barbero Barrera
published three patents and 1 exploitation contract and has participated in more than 20 research projects and coordinated another 11. Currently, she is the coordinator of the Lime4Health project, which focuses on the IAQ at schools. She has a h-index of 17 (Scopus) and 16 (WoS) with an average of 12.72 citations per item.
The Dawn of Collaboration: Ushering in the New Era of Clean Indoor Environments Together for Everyone

Fresh from the UN side event, Healthy Indoor Air: A Global Call to Action, in New York (23–24 September 2025), we signed the Global Pledge, a landmark commitment that declares clean indoor air a fundamental public health priority. Having engaged in intense discussions with global leaders, I've had time for deeper reflection. Here are the essential shifts that, in my view, are required to achieve our goals.
Firstly, education, education, education: If people, organizations and governments are unaware or do not understand the significant implications poor IEQ has on health and wellbeing there will be no impetus to change at a time when a radical change is required. Improving ventilation, building practices, construction, technology and design at the margin will only accelerate poor IEQ to become the leading cause of early mortality and ill health at a global scale.
Secondly, if you can’t measure IEQ, it remains invisible, and invisibility is the enemy. Visibility, conversely, is being able to openly monitor the IEQ of a building – a public space, a place of worship, a home, a place of
work, a hospital. Visibility means being able to see the IEQ at the hotel reception, not only in the building but also in the room you booked. In this context, visibility is IEQ’s best friend.
Thirdly, governance. We need to know, through independent testing, the performance of monitors and technologies used to collect the data and rectify IEQ. After all, poor data means poor insights, which lead to poor decisions, resulting in high levels of exposure, ill effects on health and wellbeing, and poor economic decisions on investment. This situation cannot be tolerated any longer.
Fourthly, we need to urgently move away from IEQ being 'just a number'. The ability to move beyond existing frameworks such as WELL, LEED, BREAM, ASHRAE means we need to go beyond such one-dimensional scales and into health impact assessments - a perspective that is perhaps beyond the current level of expertise of most organizations but which should be seen as an opportunity to train the next generation of IEQ data analysts, with professional certification attached. We collectively need to up our game.
Fifthly, independent regulators, regulation, and standards. Standards need to be consistent but regionally adaptable. High ambient silicate concentrations may be the norm in the GCC region, but not in Europe, and vice versa. These differences need to be acknowledged and accounted for. Compliance with these standards will not happen unless there are clearly defined 'carrots and sticks', and perhaps IEQ reporting itself needs to sit under wider scrutiny and more holistic approaches, such as ESG, to allow other variables, such as energy use, decarbonization, and human behaviors, to be included in built environment assessment.
Finally, collaboration, not competition, does not need to be greedy. Following the UN Call to Action, the time for siloed thinking and unscrupulous commerciality should end. It calls for a fundamental shift in financial regulation, moving from CAPEX to OPEX and the short-term commerciality, which already has evidence of irreparable damage globally (for a UK example, please review Grenfell). If we are to start to reduce the
global, ethic and gender inequalities in IEQ, we must all be in this together – it's IEQ for everyone or IEQ for no one. The choice is ours.
About Dr Philip Webb. Dr. Philip Webb is the CEO of Health & Wellbeing 360 and a highly experienced health professional with over 30 years in the pharmaceutical industry, academia, and the NHS. His comprehensive career includes leadership roles in sales, marketing, medical and regulatory affairs, and national commissioning and innovation. He currently serves as the industry representative on the Promoting Awareness of Air Pollution Delivery Group and as a Wellness in Tourism and Travel Standards Advisor. With a PhD in Cell and Molecular Biology and expertise spanning health economics, AI, and smart engineering, Dr. Webb is uniquely positioned to address the challenge of Indoor Environmental Quality (IEQ). As CEO, he champions a philosophy that the future of healthy environments must be people-focused, intelligent, sustainable, and enjoyable.

Dr. Philip Webb
Governance for Indoor Environmental Quality in Healthcare Facilities

When I think about governance in Indoor Environmental Quality (IEQ), I like to start with a simple question: what would have to be true for this to work? It’s a question that forces us to move beyond aspirations into the realm of practical action. This very topic was explored at a special workshop during the recent joint ASHRAE/ AIVC meeting, IEQ 2025 in Montreal, where members of the ASHRAE Environmental Health Committee, chaired by Dr. Max Sherman, debated these very issues.
The first truth is that once we accept the need for an IEQ standard, the demand for such standards is growing rapidly – it must be both credible and implementable. There is little value in a beautifully written standard if it cannot be put into practice in realworld settings.
That leads directly to the second truth: as soon as a standard comes into existence, it triggers the need for infrastructure – testing, inspection, certification, and compliance (what is often called TICC). A standard without TICC is like a law without enforcement. For governance to succeed, this infrastructure must be built in tandem with the standard itself.
Thirdly, there must be authority behind adoption. Sometimes this authority is voluntary, driven by forward-looking institutions that see IEQ as a marker of quality. In other cases, it must be mandated through regulation. Either way, without authority to specify, a standard remains aspirational rather than actionable.
Once adopted, standards need to be inspected for compliance. Here, clarity is
essential: are we talking about design standards (what should be built in) or operational processes (what must be measured and maintained)? Increasingly, the latter requires leading-edge digital monitoring tools. These systems must not only detect problems but also be adaptive and responsive. They must respond to changing environments, such as smoke from wildfires or the emergence of new pathogens. They must also adapt to the needs of individuals – from immuno-compromised patients to couples undergoing fertility treatment, where indoor conditions directly influence health outcomes.
ment in a way that directly contributes to better health outcomes.
The challenge is significant. But suppose we keep asking, "What would have to be true?" and then build the structures to make these truths a reality. In that case, IEQ governance can deliver on its promise toward safer, healthier, and more sustainable healthcare environments for all.
About Dr. John McKeon. Dr. John McKeon, CEO, iAIR Health Group, Medical Entrepreneur and Vice President, ASHRAE Ireland, is an industry pioneer, with decades of research on the intersection of the built environment, indoor environmental quality (IEQ) and public health and wellbeing outcomes. As CEO and founder of the iAIR Health Group, which also operates an international certification body for healthier indoor products, Dr. McKeon brings a cli -
IEQ governance in healthcare facilities is not an academic exercise. It is about protecting the most vulnerable, supporting staff wellbeing, and enabling clinical excellence.
Governance must recognise that IEQ is broader than IAQ. Air quality matters deeply, but so do light, sound, ergonomics, and the psychological dimensions of the built environment. A truly holistic IEQ framework links environmental factors to measurable health and wellness outcomes. Wellness, after all, is not simply the absence of harm; it is the presence of conditions that support productivity when we are awake and restoration when we are asleep.
Finally, governance must be both interdisciplinary and multidimensional. Engineers, architects, clinicians, and policymakers each bring essential expertise. But we also need to think at two levels: the health of the individual and the health of the planet. The quality of the indoor environment cannot be advanced at the expense of operational carbon; the two must be balanced.
This is the work of governance: to move from vision to implementation, from aspiration to accountability. It requires implementable standards, enforceable infrastructure, adaptive systems, and frameworks centered around both people and the planet.
IEQ governance in healthcare facilities is not an academic exercise. It is about protecting the most vulnerable, supporting staff wellbeing, and enabling clinical excellence. It is about ensuring that we build, monitor, and maintain the indoor environ-
nician’s experience to the world of building services and environmental health. Dr. McKeon is a voting member of ASHRAE’s Environmental Health Committee (EHC), shaping the Society's evolving approach to health-focused standards. He is a frequent speaker at their Annual Conferences and a published author in the ASHRAE Journal.
Dr. McKeon’s recent research investigates the limitations of historic health-related definitions in building design and how to develop more evidence-based frameworks for occupant wellbeing. He serves as Entrepreneur in Residence at the Centre for Practice and Healthcare Innovation at Trinity College Dublin, where he advances innovation at the intersection of health and the built environment. He is a member of the IWBI Healthy Workplaces Coalition and an Ambassador for the World Filtration Institute.
Dr. McKeon also represents Ireland as a national delegate to the International Electrotechnical Commission (IEC), contributing to the development of global standards. A Fellow of the Royal College of Surgeons in Ireland, he holds U.S. medical qualifications and is an accredited educator in healthy building design with the American Institute of Architects.
Dr. John McKeon



Reverse Osmosis INNOVATIONS for Environmental Challenges
By Jason Chen, International Correspondent, IFN
Today, the reverse osmosis (RO) industry has reached such a large scale that it has significantly impacted the daily lives of most people and affects to almost all industries worldwide. At a forecasted compound annual growth rate (CAGR) of 11.2%, the global market for RO system components in water treatment is expected to reach $32.0 billion by 2029, according to BCC Research.
However, like most other industries, the fast-growing RO business will also face challenges from environmental issues. However, these challenges could become the driving force behind technological innovations and new opportunities if we tackle the problems correctly.
One of the major environmental issues is RO membrane waste. The world consumes tens of millions of RO membrane modules every year, and most are discarded to end up in landfills.
From a global perspective, China is the largest consumer of RO membranes, accounting for more than one-fourth of the global market, and the second-largest producer, only after the United States. A research study from the Beijing Institute of Technology estimates that about 5.5 million 8-inch RO membranes have been discarded each year in China, accounting for 27.5% of the world's total. Therefore, solutions to deal with the RO waste problems have become a top priority. The most promising solutions to this issue include regeneration, graded utilization, conversion, materials recycling, and improvement of membrane durability.
Regenerated Reverse Osmosis Membranes
Discarded RO membranes can restore a substantial portion of their original performance after being cleaned and subsequently subjected to chemical or physical treatment. These regenerated

membranes exhibit desalination performance between that of nanofiltration (NF) and RO membranes, with permeation performance nearly restored to the original level.
With various modification or surface treatment methods, such as coating the membranes with natural sericin protein, the desalination rates of the regenerated RO membranes can exceed 90%, according to several studies. These regenerated membranes are suitable for some lessdemanding applications, such as partial desalination, RO pretreatment, material separation, and concentration.
Currently, research and development continue to improve the quality of regenerated RO membranes. The main development efforts focus on both physical modification methods, such as adsorption, coating, and doping (with nanoparticles), and chemical modification, such as chemical coupling and grafting.
Commercial practice has demonstrated that regeneration of RO membrane waste is not only environmentally friendly but also economically feasible. Runbang, a North China-based RO membrane recycling company, illustrates its business model with an example:
A RO user bought a new RO module at $3,000. After three years of the module’s service life, they sold the used module to a waste collector for $15.
The collector sold the used module to a recycler at $30.
A testing service provider tested the collected modules for the recycler to determine if they could be regenerated, at an approximate cost of $70 per module.
A machine maker sold testing equipment to a testing service provider for approximately $7,000.
The recycler cleaned and repaired the regenerable RO module, then sold the regenerated module to a user for approximately $1,500, which secured the recycler’s main profit.
The recycler purchased an interfacial polymerization coating machine for $40,000 from a machine manufacturer.
The recycler broke down the nonregenerable materials into plastic pellets, such as polysulfone (PSF), polyamide (PA), acrylonitrile butadiene styrene (ABS), and polyvinyl chloride (PVC), and sells them to a regenerated pellet user at about $9. Although this is only a small amount, it does offset part of the cost –for example, a recycler sold 20 metric tons of regenerated PSF pellets to an automotive part manufacturer and generated a revenue of $40,000 per month.
A water treatment plant could save an average of 25% on costs by purchasing half-price regenerated RO modules instead of virgin modules. However, the regenerated ones have a relatively shorter service lifespan.
Conversion
RO membranes, which consist of a porous support layer and often a PA separation layer, can be converted into ultrafiltration (UF) or microfiltration (MF) membranes by selectively oxidizing and degrading the PA layer. For instance, NaClO-treated RO membranes have achieved permeabilities and retention performance comparable to those of commercial UF membranes. Potassium permanganate treatment can remove the active layer entirely, enabling conversion to MF membranes suitable for pretreating wastewater, which achieves high turbidity reduction and high suspended solids removal.
Additionally, through the appropriate treatment of discarded RO membranes, their separation properties can be modified to achieve NF performance. NF membranes have a performance range between RO and UF membranes. Studies have demonstrated that discarded RO membranes often exhibit twice the

water permeation flux of new membranes, while their salt rejection rate decreases to 35–50%. Their mass transfer characteristics are comparable to those of NF membranes, making them suitable for applications such as seawater pretreatment, brackish water desalination, preparation of isotonic or hypertonic solutions, and artificial seawater production for coral research. Chemical modification approaches –such as immersing discarded membranes in polyamine solutions or treating them with NaClO – have been shown to adjust retention characteristics, flux, and fouling resistance to match those of commercial NF membranes.
Discarded RO membranes can also serve as structural supports for fabricating anion exchange membranes. For example, by removing the PA layer and coating the supports with anion exchange resin blends, regenerated membranes are produced that have high selectivity – comparable to commercial products- and a high desalination rate for brackish water.
Graded Utilization
Graded utilization is a design where fresh and high-rejection membranes are placed at the upstream end of the filtration system, with older and low-rejection membranes placed behind it. This approach, similar to the Internal Segregated Design (ISD), reuses older membranes instead of discarding them. Additionally, this design can also reduce permeate conductivity and pressure differentials in an RO system, thereby extending the membrane's service life.
Improvement of Membrane Durability
Extending membrane’s service life not only is critical for cost reduction, but also help increase the RO membranes’ lifespans and thus reduce the amount of discarded waste. Enhancing resistance to fouling and chlorine degradation minimizes the need for frequent cleaning and replacement, leading to improved system stability and reliability, which in turn results in a longer service life.
Membrane fouling remains one of the principal limitations of RO membranes in real-world applications. Current research and development efforts to mitigate fouling focus on three main strategies: (1) surface modification technologies, such as grafting hydrophilic groups or applying anti-fouling coatings, which enhance surface hydrophilicity and thereby reduce contaminant adsorption; (2) optimization of operating conditions, including adjustments to feedwater quality, pressure, and flow rate, to minimize fouling and extend membrane lifespan effectively; and (3) development of self-cleaning materials, such as photocatalytic and antibacterial membranes, which can degrade or inhibit foulant accumulation under specific conditions.
The poor chlorine tolerance of RO membranes could limit their use in certain applications and reduce their service life. Current development efforts focus on three key areas: (1) material modification, where chemical modification to PA membranes – such as introducing chlorine-resistant functional groups or incorporating antioxidants and stabilizers – enhance chlorine resistance and long-term stability; (2) process innovations, including refinements to the interfacial polymerization process, such as the use of buffer layers to better control polymerization rates, which produce membranes with improved chlorine tolerance and performance consistency; and (3) integration with complementary technologies, such as ultraviolet disinfection and activated carbon adsorption, which reduce residual chlorine levels in feedwater, thereby mitigating membrane damage and extending operational lifespan.
Materials Recycling
As mentioned above, PSF, PA, ABS, and PVC can be recovered from RO membrane waste. Other examples include
converting waste membranes into carbon materials through pyrolysis, which can then be used as adsorbents or incorporated into construction materials such as bricks, and mechanically grinding waste membranes to produce fillers for concrete.
Energy Saving
In addition to waste management, another environmental issue the RO membrane industry faces is energy saving. RO uses around 2.5 to 3.5 kilowatt-hours (kWh) per cubic meter of treated water. As global production of desalinated water through RO technologies reaches tens of billions of metric tons, the associated energy consumption has risen to the scale of hundreds of thousands of gigawatt-hours (GWh) a year. High energy consumption results in high greenhouse gas emissions, which undoubtedly have a negative impact on our environment.

Currently, the RO industry mainly works on two areas to reduce the energy consumption:
Development of novel materials: Advances in PA chemistry and composite materials can improve membrane performance, reduce required operating pressure, and consequently lower energy demand. For instance, incorporating nanoparticles into polyamide matrices by nanotechnology can enhance membrane structure, increase water flux, and reduce energy consumption.
Optimization of membrane structure: Innovations in membrane architecture – such as increasing porosity or tailoring surface properties – can boost water permeability and reduce the required operating pressure. For example, RO membranes supported by vertically aligned carbon nanotubes have demonstrated both higher water flux and superior salt rejection rates.

Energy savings not only mitigate the negative environmental impact of RO but also reduce the operational costs of RO systems and increase their competitiveness in the water treatment market. Therefore, it has become the hottest topic in the research and development of RO technologies.
References
1. Siyi Huang, Changhao Liu, Haixia Wu, "Life cycle sustainability assessment of end-of-life reverse osmosis membranes management options," Desalination Volume 613, October 15, 2025, 119050

Jason Chen is an international correspondent for IFN. He is a leading journalist covering the fiber industry in Asia and a senior analyst who has published more than 50 books and reports for polymers, composites, and other advanced materials and technologies. He can be reached at jasonchen200501@hotmail.com.

•
•
•
• Media, pleat support
•
•

PROGRESSIVE FILTRATION for Cleaning Metalworking Coolants
By James J. Joseph
Tank-side cleaning of metalworking coolants is growing in popularity with of all the advantages of cleaning at the machine without all the extra handling. There are three basic concepts:
This article focuses on manufacturing parts made of steel or ferrous materials. It does not cover manufactured parts made of nonferrous materials.
1. Remove the total volume to a remote cleaning device which has its own holding tank. Then send the cleaned fluid back to the machine’s tank. This is a remove, repair and replace maintenance procedure.
2. Constantly recirculated a portion of the sump’s volume through a portable cleaning device without removing the total volume at one time.
This is a progressive filtration procedure.
3. Add a cleaning device to a machine’s sump to filter the coolant while the machine is still operating. This is a sidearm approach. Note all three use the same schematic as shown in Figure 1.
to the science of filtration system design.
Progressive Filtration
Progressive filtration is when a portion of the volume of liquid in a tank, with a fixed amount of suspended material, is continuously recirculated through a cleaning device and returned to the tank. As it is recirculated, the just cleaned portion mixes with the balance of the fluid to reduce the concentration of remaining contaminants. The fluid is progressively being cleaned as long as no other contamination is introduced during the cleaning period.
Less efficient devices attempt to reach the 99.9 percent goal, but they need more than seven turnovers to accomplish the task. Regardless of the efficiency the majority of the contaminants are removed at seven turnovers.
Settled Material
The use of any concept depends upon the elimination of material which either settles to the bottom or floats to the top. Many tanks should be cleaned of this material so only suspended material remains to be treated, in some cases a slight agitation helps prevent premature settling.

Progressive Filtration Axiom
The “remove and repair” and “sidearm” concepts are easy to understand. However, the progressive filtration concept has many subtle fundamentals which influence its success in cleaning a reservoir. Many believe that all they have to do is to hook up a sidearm cleaning device to a machine’s sump (while it is down) and let it run for a short time to clean the fluid; usually the quicker the better. However, the importance of the cleaning time is a major component to successful performance. This article explains the nuances of progressive filtration and attempts to convert the art of filtration system design
The phenomenon of progressive filtration has an axiom that a 100 percent efficient cleaning device will remove over 99.9 percent of the original suspended material after the flow rate through the cleaning device has achieved seven turnovers of the entire volume of the reservoir. This statement has a direct applicability to actual practice, but caution is advised to recognize the practical limits of this thinking. There is more on this in the book, Coolant/ Metalworking Fluid Filtration 3rd Edition - Technology Update (see page 26). Obviously, the 100 percent efficiency factor is the ultimate accomplishment and there are few devices which are economically justified to achieve this target.
Figure 1 shows a simple schematic of a sidearm device connected to a machines tank or remote facility. This is the same arrangement as a progressive filtration concept. To be successful, more thought and planning are required. The following paragraphs offer a quick definition of the critical factors in progressive filtration.
Figure 2 is a family of curves reflects the amount of contaminants remaining in the fluid versus time at four different device-efficiency levels; less than 25 percent, 25 to 50 percent, 50 to 75 percent, and 75 to 100 percent. The unit for operating interval is one turnover of the reservoir. The title uses the term “clarification” to cover all cleaning devices regardless of their mode of operation. These curves are developed with established models from filtration studies on a wide range of applications. They are prepared to fit known factors found in typical applications and to compensate for some of the realities of data collection and interpretation.
The curves are not absolute because of the many other factors and unknowns which take place during the recirculation

of liquid through a cleaning device. They are not really smooth since most devices will react differently as the amount of suspended material in the fluid changes in concentration. However, it is possible to use these as guides to project a feasible performance or make flow rate adjustments to achieve better turnover rates. Also, it can be seen that a device with low efficiency could yield an “acceptable” clarity level for an application.
The success of the progressive filtration cleaning function depends upon many factors, but the two most important parameters are; the efficiency of the cleaning device and turnover rate of the volume in the sump.
Efficiency
In this industry the term “efficiency” is a difficult parameter to measure while a unit is working. A filter’s efficiency changes as it loads with the contaminants. Centrifuges have a high and fairly consistent efficiency, but it could change when the ratios of solids to liquids vary. Other separators have a lower efficiency which is also dependent on the ratio of solids to liquids.
All of this is treating the suspended material which can be drawn into the pump’s suction. Another part of tank cleaning is to take the steps to remove settled and floating material if they cannot affect performance.
Turnover
Turnover is defined as a point where the tank’s entire volume of liquid passes through a cleaning device at its designed flow rate. For example, a filter flow rate of ten GPM, working on a tank with 100 gallons will turnover the volume every ten minutes.
Applying Progressive Filtration
Knowing that seven turnovers is a key factor, here are points to consider:
1. Initial thoughts should be to see what is needed to approach seven turnovers.
2. A large tank should have a higher flow rate than a small tank.
3. Time to reach a turnover is an important parameter for machine downtime.
4. Tank cleaning is intended to extend the fluid’s life; not keep it totally clean.
5. The machine can operate with some contaminants in the fluid. It does once it starts working.
6. Seven turnovers may be too long and not really needed.
7. Time to service the device, as needed, during the cleaning cycle.
8. Note the different turnovers at a given level of contaminants left in the system.
9. A small increase in flow rate could make a significant difference in turnover rates.
10. There are four factors; sump size, downtime, device selection and flow rate.
Of the four factors in the progressive dilution concept, two are fixed; sump size and maximum time the machine can be down. The other two, device selection and flow rate are flexible within a reasonable range of options.
The following typical scenario reveals some thought processes: the calculations are simple. They are not rocket science. They are just simple arithmetic ,but are important in selecting and sizing equipment.
Given:
• Sump capacity of 250 gallons.
• Filter selected for 20 GPM and has been properly sized for the application.
• Turnover every 12.5 minutes.
• Seven turnovers would have the machine down for about 1.5 hours.
If downtime is too long for the machine’s production schedule, here are some options to reduce the time:
1. Select a higher capacity cleaning device for a flow greater than 20 GPM. Probably this step is the most practical; i.e., if bag filters are used, add more bags in parallel. Or, with centrifuges use a larger unit.
2. Use the most efficient device possible; most of the time a filter or centrifuge are already at the best level. The filter must be sized for the application to avoid frequent stopping to change the media.
3. Run it at the number of turnovers the machine’s downtime can tolerate and see if the clarity level is acceptable. For example, the curves show what can be achieved if 20 percent left in the system is acceptable; 1.5 to 3.3 turnovers.
4. If none of the above is feasible, drain the sump, transport the fluid to a remote cleaning operation, and refill with cleaned fluid from the remote operation. The remote operation should have a longer running time capability.
Word of Caution
Since progressive filtration is a multifaceted phenomenon, it is important to understand that the information offered here is presented in good faith as a guide to understanding the basics of sump cleaning. All factors should be evaluated by everyone involved to make sure there are no unknowns which could influence the selections of equipment and time.

James J. Joseph is a consultant in industrial liquid filtration and is author of the book, Coolant Filtration 2nd Edition, Additional Technologies He currently owns Joseph Marketing in Williamsburg, Virginia and can be reached at 757565-1549 or via email at josephmarketing120@ gmail.com@verizon.net. He serves on the editorial board of the International Filtration News.
Filtration for a Healthy, Resilient, and Sustainable World
Global Leading Experts Converge Virtually to Discover the Latest Innovations & Opportunities
The World Filtration Institute 2025 Annual Virtual Conference will take place on December 2 and 3, 2025.
“This year’s conference theme, ‘Filtration for a Healthy, Resilient, and Sustainable World,’ will explore how filtration serves as a key tool in meeting global sustainability challenges and how integrating new sensor and data technology is essential to extending our future perspectives,” says Christine Sun, Ph.D. President, World Filtration Institute (WFI).
The event features six main sessions chaired by notable industry professionals. It includes 36 speakers, the announcement of the WFI Product of the Year Award winners, and a graduation ceremony for our Certified Filtration and Separation Specialist (CFSS) students.
WFI session sections and their chairs include:
• Filtration Innovations for Resilient and Healthy Buildings: Tyler Smith
• New Technologies for Sustainable Filtration: Mike Clark
• Filtration Advances for Emerging Technologies: Nick Agopian
• Circular Economy and Sustainable Filtration: Richard Lydon
• Regulations, Tariffs, and Resilient Global Operations: Paul Marold
• Smart Filtration: Sensors, Data, and AI Innovations: John McKeon
The full conference schedule is now available, as well as speaker information, on WFI’s website conference page at https://www.wfius.org/wfi-2025.
“On behalf of the WFI 2025 organizing committee and speakers, we invite you to join us online for WFI 2025,” shares cochair Tyler Smith, Vice President Global Lifecycle Solutions at Johnson Controls.
“The WFI distinguished international experts will explore the latest advances








in filtration and separation technologies for clean air and clean water, and their critical roles in protecting human health, safeguarding critical equipment, and improving the environment – all contributing to building a healthier, more resilient, and sustainable world.”
WFI will present the Product of the Year Awards at the end of Day 1. The categories to recognize excellence are Filter Element, Filter Device, and Filter Media, with special recognition for Emerging Technologies and Innovative Products. There is no charge to enter a product in our competition, and registration is
open until November 1, 2025. Find details at https://www.wfius.org/productof-the-year.
During the event, the institute takes the opportunity to host a graduation ceremony for students in WFI’s Certified Filtration and Separation Specialists (CFSS) Program, a cornerstone of the WFI mission. Each year, dozens of students from around the world, along with representatives from filtration industry companies, academic institutions, and government entities, participate in what WFI believes is the most comprehensive and cost-effective education program in the industry. A full listing of courses and a program description are available on the WFI website at https://www.wfius.org/ cfss-2025-program.
“Together at WFI 2025, we will explore novel ideas, technology advances, and strategies to address the challenges faced by the global filtration industry to achieve a cleaner, healthier, and more sustainable world,” shares Paul Marold, CEO, Aeristus, Inc. “We look forward to welcoming you to the event.”
www.wfius.org
John McKeon
Paul Marold Mike Clark
Richard Lyon
Nick Agopian Tyler Smith


AHR Expo Invites HVACR Professionals to the Big Show
The AHR Expo 2026 (International Air-Conditioning, Heating, Refrigerating Exposition), being held in Las Vegas, on Feb 2-4, 2026, is a fast-paced week to learn, reconnect, peruse, and demo everything new coming to market in HVACR. The 2025 show welcomed over 50,000 attendees to interact with 1,878 exhibitors, including suppliers across the supply chain. It attracts HVAC Industry Professionals, Suppliers, Manufacturers, General Contractors, Mechanical, Electrical, and Plumbing Contractors, Controls, Manufacturers, and Integrators, to name a few. The show is co-sponsored by ASHRAE and AHRI, and is held concurrently with ASHRAE's Winter Conference.
The event continues to deliver highquality and timely educational industry seminars, the AHR Panel Series, For-Credit sessions, New Product Theaters, and the popular Podcast Pavilion. This year, the event provides attendees with critical information on trending topics impacting the future of HVACR. These key areas of focus are:
AI & Smart Controls:
Presenting new opportunities for enhanced building automation.
AI and smart control innovations have long been integral to building automation, but recent advancements are opening new opportunities to revolutionize the HVACR industry. These technologies improve system efficiency, reduce energy consumption, and enhance user comfort. By leveraging real-time data analysis, intuitive machine learning, IoT integration, and two-way communication between buildings and owners, they enable optimized performance, predictive maintenance, and sustainable, cost-effective solutions.
Plumbing & Mechanical:
Enhancing performance and reducing energy consumption.
Plumbing and mechanical innovations are poised to contribute to growing trends in the HVACR industry as it moves toward greater decarbonization and energy efficiency. The integration of AI and other applied smart technologies is a driving factor for improvements in system
efficiency and reliability. Real-time monitoring, along with more precise predictive maintenance capabilities, is also enhancing performance and reducing overall energy consumption.
Refrigerants: Keeping pace with changing regulations, system design, and safety protocols.
HVACR continues to undergo significant regulation changes. Central to these changes are A2L refrigerants, which are considered mildly flammable, safer, and more environmentally friendly alternatives to traditional, high-GWP options. Global governments move to tighten regulations to phase out these high-GWP refrigerants, and the HVACR industry consistently faces new challenges and opportunities for system design and safety protocol.
Decarbonization:
Reducing energy-related carbon emissions is at the forefront of global HVACR industry efforts. Almost 40% of global energy-related carbon emissions stem from the built environ-
The Premier Industry Show Takes On Las Vegas
ment, positioning the HVACR industry at the forefront of efforts to confront climate change. The pursuit of ambitious decarbonization goals will continue to impact every facet of our industry, encompassing the design and production of new equipment, the establishment and implementation of evolving regulations and standards, the incorporation of enhanced materials and technologies like refrigerants, building automation systems including AI & Controls, and more. It will involve managing energy sources and consumption, addressing distribution and supply chain challenges, ramping up communication and education industry-wide, assessing the financial viability and sustainability of proposed solutions, and more.
Workforce Development:
Addressing escalating industry workforce shortages and training gaps. The skilled trades are facing a critical shortage of labor and professional workers. As an aging workforce exits the industry faster than new professionals
enter, the gap continues to widen. This challenge is further intensified by rapidly evolving regulations and increasingly complex training requirements, placing greater demands on the existing workforce to uphold industry standards. The industry must work together to promote HVACR career opportunities to the next generation while ensuring ongoing training and development for those already in the field.
Ones to Note
Building Automation and Control (BAC) is addressed in one of the first sessions of the event: “Navigating Complexity. Escalating Opportunity. Today, Tomorrow & The Future” offers a state-of-theunion-style address where the industry has been and where it’s headed. Panelists will reflect on the milestones that shaped building automation and provide forward-looking insights on AI, cloud, interoperability, human-centric design, continuous learning, cybersecurity, and data-driven ecosystems.




Other BAC sessions in this area include Indoor Air Quality, Harnessing AI, The Evolution of Master Systems Integrators, Software Platforms, Next Generation Transmitters, Apps, and Gas Detectors. Corporate ESG is driving Energy Conservation and Efficiency initiatives. Multiple sessions address innovative ways to increase system performance and save energy, and create healthier environments. One ASHRAE training includes “Decarbonization Tactics: Making Buildings Grid-Interactive,” which explores controllable energy-consuming systems that can significantly adjust energy usage patterns with the right communications and controls infrastructure.
Also, “Breathe Better, Save More: DOAS for Healthier, Lower-Load Buildings” explores how dedicated outdoor-air systems (DOAS) enhance indoor environmental quality by delivering fresh, dehumidified air independently of space conditioning. It will explain how DOAS decouples latent and sensible loads, improving ventilation effectiveness, humidity control, and air purity. It will also demonstrate how DOAS reduces overall HVAC heat load by offloading ventilation demand from central systems, enabling smaller, more efficient cooling units.
Speakers from the Sheet Metal and Air Conditioning Contractors’ National Association will talk on “SMACNA System Air Leakage & HVAC Duct Systems Inspection.” Their standard addresses leakage testing of any portion of, and up to, the entire forced air system. This in-depth look highlights significant changes for inspection of commercial HVAC duct systems for compliance with SMACNA Standards.
The event will take place at Las Vegas Convention Center, Las Vegas, NV. www.ahrexpo.com
Axine Water Technologies Appoints Andrew Mrasek as Chief Revenue Officer
Axine Water Technologies Inc.,

a Canadian leader in wastewater contaminant treatment, announced the appointment of Andrew Mrasek as chief revenue officer (CRO). Mrasek brings nearly two decades of experience in global sales, marketing, and strategic business development across multiple industries, including industrial automation, renewables and advanced engineering.
Mrasek joins Axine from Nidec Motor Corporation – Control Techniques, where he most recently served as General Manager for the Americas. In that role, he successfully led a team of more than 80 professionals, driving over $20 million in sales growth in just two years and delivering recordbreaking revenues of $96 million.
During his tenure at Nidec, Mrasek spearheaded major organizational transformations, from restructuring international operations to developing targeted market segments in HVAC, pumping, elevator systems and machinery automation. His leadership extended into digital innovation as vice president of sales and marketing, developing system configuration tools, top to bottom lead generation processes, and Salesforcedriven forecasting measures – significantly improving sales efficiency and operational planning.
Earlier in his career, Mrasek held technical and commercial positions with Emerson Industrial Automation, Robert Bosch LLC, and Delta Air Lines. He holds both an MBA from the Georgia Institute of Technology College of Management and a Bachelor of Science in mechanical engineering from Georgia Tech’s College of Engineering. www.axinewater.com
FLS to Deliver the World’s Largest Filtered Tailings System
Following a long-standing partnership, a progressive Indian miner and steelmaker has selected FLS to deliver core mining technologies to what is set to become one of the world’s largest, most efficient and sustainable iron ore beneficiation plants globally. This is the fourth consecutive order that FLS has received from the customer within the past nine months.

The order includes the delivery of the world’s largest filtered tailings (“dry tailings”) system comprising of twenty-two 4.2-meter x 162-sq. meter Horizontal Belt Filters (HFB), which also will be the largest of their kind in the world, as well as twelve 12 x 55-meter diameter high-rate thickeners (HRT). The technologies are expected to be delivered to the customer in 2026.
The addition of these technologies to the flowsheet and their crucial placement throughout the overall process flow demonstrates FLS’s commitment to sustainability, in this case, particularly water recovery. Furthermore, this order confirms FLS’s technology as the preferred solution for resource conservation and operational efficiency.
The value of the order has not been disclosed. www.fls.com
Thermo Fisher Scientific Completes Acquisition of Solventum’s Purification and Filtration Business

Thermo Fisher Scientific Inc. a global leader in science, announced the completion of its acquisition of the Purification & Filtration business of Solventum for $4.0 billion in cash. With the transaction complete, the business, which is now Thermo Fisher’s Filtration and Separation business, is part of the Life Sciences Solutions segment.
The transaction includes Solventum’s Purification & Filtration business serving Bioprocessing Filtration, Healthcare and Industrial Filtration, and Membranes. The business strengthens Thermo Fisher’s bioproduction offerings with advanced filtration technologies that improve quality and efficiency across upstream and downstream workflows. In addition, its robust industrial filtration and membrane solutions will expand our reach into industries requiring ultra-pure water, including battery, semiconductor and medical device manufacturing. For the full year 2025, the business is expected to generate approximately $750 million of revenue. www.thermofisher.com
Ricardo Bernal Joins WaterSurplus as Senior VP of Business Development and Sales
WaterSurplus, a leader in sustainable water treatment, announces that Ricardo Bernal, an experienced and highly respected executive in the water industry, has joined the company as Senior Vice President of Business Development and Sales.
Bernal’s deep experience in the water industry spans more than 25 years and encompasses engineering, product management, project finance, and business strategy, with deep technical expertise in water/wastewater, desalination, biosolids, and PFAS.
Immediately prior to joining WaterSurplus, he served as Senior Vice President of Project Development & Strategy for Heartland Water Technology, where he was responsible for overseeing and managing globally all commercial aspects of the company’s projects under Design-Build/Build-Own-Operate and recurring reve-
nue models, from inception through commercial operations. He also spearheaded business development efforts for new markets and technologies within the water business.

Earlier, he was the O&M Sales Manager for Jacobs/Ch2mHill’s Water Business Group and served as Managing Director for Abengoa’s Industrial Water Division. As Senior Project Developer at GE Water he developed multi-million-dollar desalination and water reuse projects globally and drove business development across GE Water product lines. Bernal started his career in the water industry at Ionics, Incorporated, serving as its LAM Sales Manager, and MBR Product Manager. www.watersurplus.com
Andrew Mrasek
Karla Butler Named Vice President & General Manager for DuPont Water Solutions
DuPont announced it has named Karla Butler as the Global Vice President and General Manager of DuPont Water Solutions, a business focused on filtration and specialty-separation technologies with high growth potential.
Butler brings 35 years of experience in business, commercial, and operational leadership at global multi-industrial companies, including DuPont.
“I am truly honored to lead DuPont’s Water Solutions business, a purpose-driven team committed to addressing some of the world’s most critical challenges,” said Butler. “I am excited to work alongside my new colleagues, customers, and partners to increase access to clean water and sanitation, enable more industrial water reuse, produce healthier foods and medicines, and support the development of cleaner energy sources.”
DuPont Water Solutions’ technologies are helping to purify more than 50 million gallons of water every minute in 112 countries across the world. DuPont offers market-leading technologies to address a variety of challenges faced by water treatment municipalities, seawater desalination plants, and industrial water users, including the microelectronics industry, through a broad portfolio of membranes, resins and complete systems. The team is innovating solutions that can help balance the world’s growing water and energy demands, with products that help maximize the availability of electricity, lithium and green hydrogen. The business also supports the life sciences industry with solutions for drug development, crop-to-table processing, protein-rich diets, and innovative healthcare. www.dupont.com
Aquatech Acquires Koch’s Direct Lithium Extraction Business
Aquatech has acquired Koch Technology Solutions’ (KTS) direct lithium extraction (DLE) business, integrating the Li-Pro™ Lithium Selective Sorption (LSS) technology and extensive Li-Pro IP portfolio into the PEARL™ process technology platform.

The acquisition of KTS’ Li-Pro LSS technology adds direct lithium extraction to Aquatech’s extensive process flowsheet IP, lithium conversion and crystallization capabilities. With this addition, Aquatech’s PEARL platform becomes the only commercially proven, endto-end flowsheet solution for lithium processing. Spanning lithium extraction, purification and refining, the PEARL process technology platform delivers high-purity battery materials for electric vehicles (EV) and utility-scale electricity storage systems (ESS).
The integration and optimization of upstream and downstream lithium processing will empower lithium resource owners with modularized process solutions at scale. This approach improves project bankability by removing process risk, accelerating project schedules and reducing the total cost of lithium production. Li-Pro LSS will be available under technology license as part of the PEARL full flowsheet licensing offerings.
As part of the acquisition, all ongoing lithium extraction projects utilizing Li-Pro technology and associated licenses, agreements and performance guarantees will be transferred to Aquatech. www.aquatech.com
Elessent Clean Technologies Acquires Sulphurnet

Elessent Clean Technologies in Missouri announced the acquisition of Sulphurnet, a leading provider of advanced filtration solutions based in the Netherlands. This investment supports Elessent’s mission to deliver comprehensive, innovative technologies that support cleaner, more efficient industrial processes worldwide.
Sulphurnet, a leading provider of sulfur processing technology as well as advanced filtration solutions, delivers outstanding impurity removal from sulfur feed streams –a critical process for optimizing sulfuric acid production by ensuring reliability and maximizing uptime. With a versatile lineup tailored to various operational needs, Sulphurnet’s offerings naturally enhance Elessent’s capabilities across the sulfuric acid, chemical, chlorine, and green hydrogen sectors.
“We are thrilled to welcome Sulphurnet to the Elessent family,” said Eli BenShoshan, CEO, Elessent Clean Technologies. “This acquisition is a natural fit for both companies. It enhances our ability to serve our customers with a broader range of high-performance technologies and strengthens our global presence in key markets.”
The acquisition is effective immediately, and integration efforts are underway to ensure a seamless transition for customers and partners. www.elessentct.com
INEXA and IonClear Form Alliance to Deliver Water Reuse Solutions
INEXA Aqua Services SL, a consulting leader in engineering and seawater desalination plant design and performance optimization, and IonClear, a global innovator in reverse osmosis (RO) and nanofiltration (NF) membrane technology, has announced a strategic alliance to deliver high-efficiency water treatment systems for desalination, reclamation, and reuse applications worldwide.
Drawing on more than two decades of engineering and operational expertise, the partnership will focus on designing and

building systems that help operators produce more clean water with less energy, extend equipment life, and reduce environmental impact. These systems are engineered to meet the wide range of specifications required by varying feedwater conditions, whether seawater, brackish sources, or industrial process water. www.ionclear.com

STATEMENT OF OWNERSHIP
CLASSIFIED MINI MART
•
•
•
•
•



WELL ASSEMBLED
Custom welded assemblies. Unified expertise. Beverlin Specialty Tube and Perforated Tubes have joined forces, bringing together over 100 years of expertise—from perforated cores and filter elements to fully welded assemblies. By uniting our capabilities, we deliver complete solutions that are truly well assembled—in both the products we build and the way we work. Every project reflects the same high standards our customers have always trusted.
To learn more, visit






